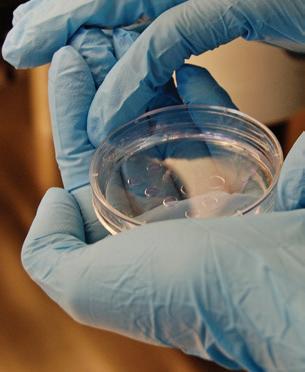

Безплатно издание Брой 18 Списание за репродуктивно и семейно здраве и здраво семейство МОЯТ ПЪТ КЪМ ДЕТЕТО БОРЯНА ДИМИТРОВА МОЯТ ПЪТ КЪМ ДЕТЕТО БОРЯНА ДИМИТРОВА СБОРНИКЪ на Ангелина Бонева НАШИТЕ ДОКТОРИ Д-Р МАРИЕЛА ДАСКАЛОВА Д-Р ВАСИЛ ДАСКАЛОВ РОЛЯТА НА ПРЕНАТАЛНИТЕ ТЕСТОВЕ Д-Р БОРИС СТОИЛОВ В КАДЪР: ЕМБРИОЛОГЪТ Д-Р НЕЛИ МАНОЛОВА-ТАСКОНИДУ ЦЕННИЯТ ПРОГЕСТЕРОН Д-Р ЯВОР МАЛИНОВ НАШИТЕ ДОКТОРИ Д-Р МАРИЕЛА ДАСКАЛОВА Д-Р ВАСИЛ ДАСКАЛОВ Д-Р ДАНИЕЛ СТАВРЕВ ЗА НЕВРОПЕЛВИОЛОГИЯТА Д-Р ДАНИЕЛ СТАВРЕВ ЗА НЕВРОПЕЛВИОЛОГИЯТА Д-Р МАРГАРИТА ТАУШАНОВА И БОРБАТА ЗА ЖИВОТ РОЛЯТА НА ПРЕНАТАЛНИТЕ ТЕСТОВЕ Д-Р БОРИС СТОИЛОВ ЦЕННИЯТ ПРОГЕСТЕРОН Д-Р ЯВОР МАЛИНОВ СБОРНИКЪ на Ангелина Бонева В КАДЪР: ЕМБРИОЛОГЪТ Д-Р НЕЛИ МАНОЛОВА-ТАСКОНИДУ ОТ БЕБЕ ЗА БЕБЕ Д-Р СЪБИНА ПЕРСЕНСКА ОТ БЕБЕ Д-Р СЪБИНА

да за лечение на тазовата болка
Нещата от живота




Вие ме карате да искам да бъда мечтател! 34 Пренаталният тест не е па нацея, но е добро продължение на скрининг в първи триместър 40 Искаме да видим щастието и любовта в очите на пациенти те си 46 Профилактичната медицина ще спаси света 52 Ода за доброто 54 Новини в бяло 58 Фактори за възпаление и ендо метриоза: Втора част 64 Всяка жена заслужава най-до брата здравна грижа за своята бременност 70 Сборникъ за здраве 80 Борба за живот 84 Ценният прогестерон
Издател: Фондация „Искам бебе” Главен редактор: Радина Велчева

Редактори: Вяра Кръстева, Ива Лалова, Нели Христова, Християн Гьошев
Дизайн и предпечат: „Ел Креатив” ООД Даниела Гарибска
Снимки: Shutterstock.com Корица: Калина Арсова, "Калина ме снима"
Фондация „Искам бебе” Контакти Адрес: ул. „Лавеле” №19, ет. 3 София 1000 Тел.: +359 2 427 04 37 +359 887 520 820 0700 700 17 Национална телефонна линия на „Искам бебе” В работен ден: от 10.00 до 16.00 ч. Тук можете да получите информация за пред стоящите групи за емоционална
1 БРОЙ 18 І СЪДЪРЖАНИЕ
„ИСКАМ БЕБЕ” БРОЙ 18
подкрепа на двойки с репродуктивни проблеми, организи рани от фондацията. Разговорът се таксува според тарифния ви
Пишете ни на:
Facebook:
Списание „Искам бебе” е запазена марка на фон дация „Искам бебе”. Никаква част от това из дание не може да бъде възпроизвеждана и/или публикувана без изричното писмено съгласие на издателя. СЪДЪРЖАНИЕ 64 6 28 80 40 2 От редактора 6 Мечтая да няма семейство без рожба! 14 Бъдете добри! 20 Невропелвиологията – надеж
план.
info@iskambebe.bg
Iskam Bebe
28
32
Радина Велчева, основател на Фондация „Искам бебе“

Снимка: Калина Арсова
Всичко
– Християнският празник, в който утихваме пред Мъд ростта на Светиците и празнуваме пребъдването на любовта, вяра та и надеждата – се осмелих да представя пред най-обичаните си хора, в родния Добрич, моята малка книжка „ОсЪновените ангели“. Вълнение то беше неописуемо. Върнах се в детството, в училище и сякаш порас нах отново!
Идеята за „ ОсЪновените ангели“ дойде от едно детско бисерче на дъ щеря ми, което грижливо остана в мен и точно като нея няма търпение да бъде споделено, за да усмихва дните ни. Ето го: Йоанна (7 г., 7 м. и 27 дни, без един горен зъб, другият се клати): - Мамо, аз съм осЪновена, нали? Аз: - ОсИновена си, маменце. Казва се осИновена! Йоанна: - Нали каза, че си ме сънувала и си
Нашите акценти: ◆ Боряна Димитрова и благосло вията Радмил и Борил.
◆ Д-р Борис Стоилов за ролята на пренаталните тестове.
◆
Ценният прогестерон. ◆ Фактори за възпаление и ендо метриоза: Част 2.
◆ Нашите доктори: Д-р Мариела Даскалова и д-р Васил Даскалов.
◆ От бебе за бебе: Д-р Събина Персенска.
◆ С внимание при кърлежово ухапване поради риск от лайм ска болест. ◆ Споделено от „ОсЪновените ангели“. ◆ Д-р Даниел Ставрев и невро пелвиологията. ◆ Д-р Нели Манолова-Таскониду и щастието на двойките, прегър нали своето детенце.
2 І БРОЙ 18
ОТ РЕДАКТОРА
е Любов! На 17 септември
е със за главието „Осъновените ангели“. И ще разказвам за всички възможни пъ тища да станем родители! Често ми казват, че децата ми – Йоанна и Симо – си приличат толкова много! Даже хора, които не знаят, че и двамата са осиновени, казват за Йоанна, че ми е „одрала кожата“, а за Симо, че има абсолютно същия по глед и очи като на баща си!
ме виждала насън? Затова си мисля, че съм осЪновена... Обещах си, че ако някой ден напиша книга, тя задължително ще
новяването, често давам пример именно с епигене тиката. Животът на ро дителите-осиновители и осиновените деца е дока зателство за това, че оч акването, обичането, спо делянето, говоренето на истината и радостта от срещите на различните молекули ДНК, всъщност, отключват онези ензими, които правят децата ни НАШИ!
В началото, когато то ку-що бяхме осиновили Йо анна, неведнъж минувачи те по улиците ми казваха: „Честито! Толкова прилича на Вас с това чипо носле!“. Понякога се заговаряхме и споделях, че детето е оси новено и няма как да при лича на мен. В повечето случаи, хората срещу мен се стряскаха и започва ха да ми се извиняват: „Ех, съжалявам, но нищо, знам толкова случаи, в които след като осиновят дете, жените си раждат СВОЕ.“
Но това дете е толкова МОЕ, колкото и родените от утробите на майките си, и не е разменна монета – не съм осиновила дете, за да родя друго! Детето се ражда, расте и става възрастен човек със свои те си радости и неволи. Още докато са били бебе та, съм мислила за децата

3 БРОЙ 18 І ОТ РЕДАКТОРА Моята любима доц. Ми лена Георгиева от БАН ми даде първия урок по Епи генетика - наука, която ни показва моста между гени те и начина, по който жи веем живота си. Епигене тиката доказва, че гените не са наша съдба. Епигене тиката доказва с факти, че нашите мисли, чувства, начин на живот и възпри емане на света могат да направят велик еволюцио нен скок в човешкото раз витие! Когато разказвам за оси
си като за зрели възрастни хора, с които ще трябва да се гледаме в очите и да знам, че не сме се лъгали по никакъв повод и при никак ви обстоятелства. Когато са малки, си ми слим, че не разбират, и заравяме истините на възрастните в дълбоки дупки, които затрупваме с камъните на мълчание то. Да, но децата растат. Започват сами да свалят тежестите от тези ка мъни. Правят го, като за дават въпроси. Точно в тези моменти мисля, че трябва да постъпваме като нормални възраст ни и лека-полека да раз криваме на децата си ис тините за света. Както говорим за пролетта и разлистването на дърве тата, както им разказва ме за кокошките и яйцата им, или докато наблюда ваме заедно как лястови ците строят гнездата си – така можем да гово рим и за осиновяването. С история – простичко, с обич. И задължително с прегръдка. Уроците за важните неща за живота е добре да бъ дат преживени първо в допир с мама и татко! Оп итвам се в тези моменти да съм много близо до Йо анна и Симо. Прегръщам ги
и двамата, сядаме на земя та, галя косичките им, го воря бавно и тихо. Зада ваме си въпроси, карам ги да ми кажат кога съм била нервна и дали съм се ска рала в точния момент, на точния „беладжия“. При знават си грешката, но и аз виждам моите. Децата имат уникално чувство за справедливост и това ги прави много точни в на блюденията им. Замислям се, че ние, осино вителите, вече сме дос
та по-спокойни и уверени в споделянето на истина та за осиновяването, от колкото хората около нас. И да, искам да чувам друго то: „Бъдете благословени и щастливи с това дете!“, вместо: „Вие сте герои, аз не бих могла/могъл да направя тази крачка. Как така се решихте, не иска те ли свое?“. А моят отговор винаги е бил и ще остане един и същ: „Тези деца са толко ва мои, колкото никои дру


ги – дори да са родени от мен!“
Когато погледна тази снимка, наистина се за мислям:
Цвят на косата, овал на лицето, чело – еднакви!
Епигенетика в действие, нали, доц. Милена?
Въпроси нямам. Отговорът – всичко е Лю бов!
Ваша Радина
ОТ РЕДАКТОРА
4 І БРОЙ 18
















6 І БРОЙ 18 Мечтая да няма семейство без рожба МОЯТ ПЪТ КЪМ ДЕТЕТО В този брой ви срещаме с Боряна Димитрова – щастливо омъжена, прекрас на майка на близнаци! Боряна е на 40 години, от Перник е, координатор на ИС КАМ БЕБЕ за Перник и региона. Завършва средното си образование в 5-о СОУ „П.Р. Славейков“ в родния си град, специалност „Банково, застрахователно дело и пари“. В момента е студентка (по майчинство)
се среща с приятели. Кулинарията и автентичният българ ски фолклор са й особена страст. Често се шегуваме с Боряна,
новите предизвикателства я намират, защото тя е търсач на новото, на чистото и изконното! Снимки: Калина Арсова
в Медицински универ ситет, специалност „Акушерка“. Обожава семейството си, обича да пъту ва, да чете, да
че
най-щастливият чо
век, ако успея да го на правя! Животът ми беше изпълнен с много игри, за бавления и пътувания! Имаме три къщи – в зави симост от сезоните. По стоянно стягахме багаж за някъде, навсякъде има хме приятели и игрите за почваха от ранни зори, до късен здрач. Не можеше да ни омръзне на едно място, събираме багажа и хоп, отиваме в другата къща! Най-щастливи са били ми говете ми в китното сел це Дивотино, където прекарвахме цялата ва канция. Точно затова из брахме тук да растат и децата ни. Тичахме на воля по цял ден, бяхме об грижвани от баба и дядо, а приятелствата, кои то създадохме, са и до ден днешен. Опора и смисъл За родителите ми и брат ми никога няма да мога да намеря точните думи, за да кажа колко ги оби чам и колко съм им благо дарна за опората и сми съла, който ми дадоха, за да живея точно този жи вот, който имам сега! Имам най-невероятното семейство на света! От гледани сме с брат ми с много любов, топлина и грижи.
Баща ми беше най-точни ят и принципен човек. За него 12 часът беше точ но 12, нито без една, нито и след една минута! Няма ше изключения! Сега, ако беше жив, да види как се движа постоянно със за къснение, може би щеше мъничко да ми се сърди, но в мен остана онова жела ние да се старая да бъда точна и винаги навреме! Сядахме в определен час да се храним всички заед но! Как ми липсват сега тези моменти. Въпре ки строгостта си, беше много любящ и грижовен баща! Държеше се с нас по-скоро приятелски, но винаги трябваше да спаз ваме реда и дисциплина та, които по-големите въвеждаха в дома ни! За майка ми – думите, кои то ми идват първосиг нално наум, са орлица и планина! Нямаше да съм това нещо, ако не беше Тя – грижовната, всеотдай ната, обичащата, проща ващата, можещата и зна ещата как да ме изправя всеки път, когато падна, как да бърше сълзите ми, как да ме връща в дейст вителността, когато се загубя, как да ме обича –така, както само мама може да обича!
Бях безпроблемно дете, но до пубертета! О, да,
да, усмихвам се сега, но през пубертета стана страшно – не е за приказ ка! Бягах от вкъщи, биех се постоянно или бях в конфликт с някого. Сла ва богу, не тръгнах по лош път! Но пак семейството ми беше до мен – срещнах много разбиране от тях на страна и много говоре не. Научих се да изговарям всеки проблем, да споде лям и да имам тяхната подкрепа.
К ак протича един твой ден днес – с какво се занимаваш? Как съвместяваш ра ботата и грижата за момчетата? Моят ден започва от ран ни зори. Всяка сутрин ставам много рано в 5 часа. Обичайните грижи за момчетата и домаш ните задължения вървят ръка за ръка, като вина ги приоритет са Радмил и Борил. Гледам всяка сво бодна минута да съм с тях, четем приказки, иг раем, много пътуваме и се разхождаме навън сред природата. Колкото и да е натоварен денят ми, гледам да прекарвам кол кото се може повече вре ме с тях. Нямаше да мога да се справя с всичките ангажименти, ако не бяха близките ми! Освен това, съм в постоянна връзка с

7 БРОЙ 18 І МЕЧТАЯ ДА НЯМА СЕМЕЙСТВО БЕЗ РОЖБА К акво дете беше, Боби? Какви са яр ките спомени от дет ството ти и какво наследство от ценности ти завещаха родителите ти? Имах най-щастливото детство на света! Днес ми се иска да подсигуря точно такова детство на моите момчета и ще съм
пациенти с репродуктив ни проблеми.
Т и си избрала акушерството за твой път и съдба. Кое те подтикна към тази крачка? Да, така е, акушерство то е моят път и съдба, най-важното нещо след Радмил и Борил. Много късно открих себе си, но важното е, че се намерих! Минах през различни про фесии в този живот, но никога не бях удовлетво рена и себе си. Докато не се появи Жената и Чове кът в моя живот, на коя то дължа всичко, целия си свят! Д-р Персенска или Мама Перси. Тя, със своя та човечност и добрина, при един от прегледите ми зададе въпроса: „Боря на, защо не започнеш да четеш по същество?!“. Ами да, трябваше да на меря нещо, с което да се занимавам, нещо, което да върви паралелно с бор бата ми за дете, нещо, което същевременно да ме откъсва от нея и да ме държи достатъчно бли зо! Тя пося семенцето в сърцето ми! Тя ме зарази с нейната добрина и все отдайност. И нищо не е било слу чайно. Част от хората, които срещнах в уни верситета, изиграха съ
ществена роля в живота

ми, станаха част от се мейството ми! Другият Човек, на когото дължа всичко, ще остане в мо мента в сянка, поне дока то завърша. Той ми оси гури спокойствието по време на бременност та, той единствен оста на до мен по време на Ко вид, прекаран в 8-и месец (32 г.с.). Той единствен ме прегледа по време на ка рантина (да, в послед ния ден, но го направи). Той е Човекът, който не ми беше длъжен за нищо. Беше длъжен само да
бъде Човек, а за мен – и най-добрият професио налист. Винаги, когато го попитах „Какво Ви дъл жа?“, той ми отговаря ше: „Дължиш ми да бъдеш щастлива и да гушнеш ро жбите си!“. Това ще ос танат и моите думи към всяка жена, която ме по пита какво ми дължи... Без думи... Респект, докато съм жива. За Мариета и Вики (мои колежки от университе та, които ме подкрепяха по време на цялата бре менност) само ще загатна и ще им благодаря от сър
це. Първата изкара една бременност с мен. Бла годаря им, че осъзнават хуманността на профе сията си и полагат все отдайно грижи за всич ки бременни и родилки в този специален за тях пе риод. Обещала съм си, че ще гледам семействата, които жадуват за рожба, с очите, с които гледам майка си! Обещала съм си. К ога и как срещна Дани – мъжът в твоя живот? Какво е семейството за теб? С Дани сме се познавали
8 І БРОЙ 18
МОЯТ ПЪТ КЪМ ДЕТЕТО
цял живот. Живеели сме на една ръка разстояние, но никога не сме имали общи компании или допир ни точки. Той ми казва, че винаги е знаел, че ще бъда негова жена! Как така, не знам!
Всичко при нас стана мно го бързо, на 9 март дой де при мен и ми подари цветя в една торбичка и ме покани на вечеря (су пер романтично), даже не извади цветята от торбичката. Една седми ца по-късно живеехме за едно. Казах си: „За нищо на света няма да му пра
вя място в гардероба си!“. Багажът му стоя в тор би месеци. На 33 можеше да ме впечатли и спече ли само мъж с държание, с нищо друго. Така и стана. Тогава и не предполагах, че това е най-голямата ми любов и най-добрият ми приятел, бащата на децата ми и най-добрият човек, когото познавам. Сега знам, че си е заслужа вало да го чакам толкова дълго време. Животът за тези 8 години ни поста ви и поставя пред различ ни предизвикателства и трудности. Извървяхме много дълъг и труден път. Сигурна съм обаче, че любовта ни един към друг ще устои на всичко! Не само заради момчетата ни, а и заради нас самите!
Р
азкажи ни за пътя ти към децата? Колко време пътува към тях и на какво те научи този път? Пътя към децата ни про дължи 7 години, напра вихме 7 опита инвитро, като последният ни опит беше на 7 септември. Рад мил и Борил се родиха на 7 май. Нашето пътува не беше дълго и трудно, няма да лъжа. Минах през няколко операции, три загубени бременности в 9 г.с. и една биохимич на. Само знаех и вярвах,

че съм при точния човек на точното място. Мо лех се с цялото си сърце д-р Персенска да не пусне ръката ми никога! Знаех, че рано или късно неща та ще се случат. Беше въ прос на време и на много търпение от моя страна! Това беше основното, на което ме научи животът – на търпение!!! Нещата ще се случат, когато Бог е решил, а не когато ние ис каме! Но ще се случат! Г убеше ли надежда и как се справяше със страховете си? Спасиха ме вярата и май ка ми! Орлицата се беше разперила над мен и не ме оставяше нито за миг през тези 7 години. Кръ жеше. Няма път, да сме тръгнали за болница и да не е дошла. Няма! Пом ня един летен горещ ден. Казвам й: „Недей да ид ваш, ще ида сама, мно го е горещо днес“. А тя ме погледна (така, както само тя може) и каза: „Аз ще вървя тихо зад теб, не ме мисли“. Тихо, зад мен! Тези думи ме водеха – че е тихо зад мен Тя! За миг не си помислих да се откажа, нито за миг. Па дах, изправях се, позатуп вах и продължавах. Не мо жех да се откажа, заради нея, заради Дани, заради себе си.
Чудесата Пътят към децата ме на учи да вярвам в Чудесата и днес знам, че наистина чудото ни спохожда всеки ден, ако имаме очи да го ви дим. Помня, че малко преди последния ни опит инви тро, ми се обади Здравче то (Здравка Гергова – коор динаторът на ИСКАМ БЕБЕ за Северозападна България) и ми каза, че на Молебена за Чадородие в Троянския ма настир, който Дядо Сио ний чете за нас, хората, молещи се за рожба, специ
записала името
литви. На другия ден е съ нувала, че съм бременна, и ми звъни по телефона: „Бо рянка, сънувах, че тестът ти за бременност показ ва стойност 683.“ Плаках от радост за събуждаща та ми се вяра. И така, ме сеци по-късно, когато на правих последния ми опит инвитро, наистина оста нах стъписана – тестът ми за бременност показа стойност 1 683. Обадих се на Здравчето и й казах на шега, че явно просто не е видяла единицата пред ци фрата. Дълго плакахме и се смяхме заедно! Близнаците вече са били на път, но то гава още само като миниа тюрни точици любов!
9 БРОЙ 18 І
се е молила за мен и е
МЕЧТАЯ ДА НЯМА СЕМЕЙСТВО БЕЗ РОЖБА
ално
ми за мо
ралампиева. Нямаше да мога да се справя без вас, момичета. Благодарим ви от сърце! Р азкажи ни за срещата си с ИСКАМ БЕБЕ – кога и как се слу МОЯТ ПЪТ КЪМ ДЕТЕТО
По време на бремен ността ти прежи вя много кризи – и в здравословен план, и в емоционален. Как оце няваш днес пътя, по който мина – след Ковид, след тежката загуба? Изкарах най-леката физи чески и най-тежката пси хически бременност. До този момент си мислех, че една бременност е нормална след следене на всички физически показа тели. Оказа се, че не съм и предполагала – психиката е водеща. Това ще бъде и следващата ми специал ност след Акушерство то. Само да е живот и здраве! До 8-и месец ходех в уни верситета, на упраж нения и на работа. Бях непрекъснато по болни ците. Имах няколко се мейства, които не можех да оставя. А и не исках да спирам, знам как щеше да ми се отрази да си оста на у дома. Не слушах нико го! Нямаше сила, която, да ме спре. Да, ама не. Не ми е и ми нало през ума, че за един месец ще почувствам най-голямата болка и най-голямата радост. Не съм си го и помисли ла, че след толкова годи ни борба, аз ще посрещна децата си с едно счупе
чи?
ни
тето? Ах,
ди
хме много рано там, пре ди изгрев слънце, тряб ваше да запиша час за поредната хистероско пия. Толкова вече се бях изгубила и изморила. Ос таваха броени дни до Ко леда и Нова година, а на мен хич не ми беше до празник. Предстоеше ми да си направя равносмет ка за изминалата година и тя отново нямаше да бъде това, за което меч таех от дъното на душа та си. Отново годината беше белязана с една не лека операция и една загу

10 І БРОЙ 18
но крило. Без баща ми, без моята опора и помощ. Без човека, който ме гле да цял живот и последни те 8 месеца като писано яйце. Чакаше с нетърпе ние момчетата. Само пи таше: „Боб, кога ще дойде отборът?“ (така нарича ше Борил и Радмил). Под готви всичко, до най-мал ката подробност. Всичко. И тръгна. Само се обър на, погледна ме в очите и ми отдаде чест. Без да каже дума. А аз знаех, зна ех, че това е последна та ни среща. Знаех, че ще стоя до високия и стро ен бор на двора и няма да мога да го изпратя в по следния му път. Нямаше да мога и да плача – зара ди момчетата. Нямах пра во на грешка, нямах право на тъга, нито на последно сбогом. Само на „Довиж дане и до нови срещи във вечността“. Ще те носим, любими мой, с момчетата в сърцата ни, до послед ния ни дъх! Към ден днешен, Борил и Радмил са на година и шест месеца. Познават дядо си отлично на сним ка, говорят му и не спи рат да го търсят. Знаят, че вечер на небето из грява най-ярката звезда и свети само за тях. Тук е и моментът да бла годаря за помощта на Ма рия Зеленкова и Стела Ха
С какво те проме -
каузата – да помагаш и на други хора да се справят с емоции те си по пътя към де
този Игнажден пре
4 години. Ще го помня, докато съм жива! Бяхме с Дани в болница, отидо
ба в 9 г.с. Отново наша та елха щеше да остане без подаръци, отново на шият дом щеше да е тих – нямаше да има дет ски смях и глъч. Мислех си мълчаливо, поглеждах Дани тайничко – и той мълчеше. Четеше мисли те ми. Знам. Записахме дата за след Нова годи на, отново ще започнем с интервенция година та. И то в самото нача ло. Стоически издържах в болницата, макар да имах буца в гърлото, задуша вах се.
С излизането навън вдигнах поглед нагоре към небето и си казах наум: „Господи, дай ми сили да продължа по пътя, който си ми отредил. Аз вече много се изморих“. Свеждай ки глава надолу, с периферното си зрение видях изгрева и една огнено червена глава, ид вайки към мен. Това беше тя – Радина. Моята измолена само преди секунди от Бога сила. Светеше толкова ярко в мразовития ден, че стопляше всичко наоколо. Приближих се към нея и я хванах за ръце. Тези ръце – никога няма да забравя, бяха толкова топли и неж ни. Погледите ни се засякоха – не бяха нужни думи, очите ни говореха достатъчно. Имах чувството, че този Човек е бил цял живот с мен! Вече знаех, че оттук насетне ще бъде друго. След това „Искам бебе“ се превърна в моя кауза и част от живота ми. От много време насам се чувствах жива, горях. Ако всеки ден в ръцете ми се ражда нов живот или аз мога да споделя пътя на някое семейство да бъде по-лек, в тяхната борба, то аз бих била най-щастлива. Да, наистина щастлива, въпреки болката в душата си. С още един човек вървим рамо до рамо в ИСКАМ БЕБЕ – това е Юлия Живкова, жената,

11 БРОЙ 18 І
МЕЧТАЯ ДА НЯМА СЕМЕЙСТВО БЕЗ РОЖБА
стъклено сърце. Сложи ми го и ми каза: „Пожелавам ти бебе и знай, че така аз ще бъда всеки път до теб, когато имаш нужда!“ След това забре менях. Не свалих сърцето до раждането на моите синове, а после Бог ме поведе да пре дам нататък споходилото ме щастие. Подарих стъкленото сърце на любима моя прия телка от ИСКАМ БЕБЕ, която днес вече е щастлива мама на момиченце, а тя ще предаде щастливото стъклено сърце на друга наша сестричка по съдба, която още се моли за рожба. И така – нашият кръг на вяра се върти и сбъдва мечтите ни!
Сила
с която продължаваме мисията „От бебе за бебе“. Когато роди близнаците, Юлето ме прегърна и свали от врата си едно
Т и си „тупкащото сърце“ на един голям проект – създава нето на Кабинета по репродуктивно здра ве в Перник. Разкажи ни за това и за срещите си със семейства та от Перник, които се обръщат към теб? За този кабинет ще гово ря тепърва. Към момен та искам да изкажа голя мата си благодарност на Община Перник, в лицето на г-н Владимиров, кме та на града д-р Вангелова, Мими Иванова, да не про пусна някого, за отлична


та комуникация и подкре пата, която ни оказват! Също така искам да бла годаря на нашия коорди натор Здравка Гергова, която се нае с цялата ад министративна тежест по отварянето му. Благо даря ти, Здравче, за помо щта, ще си ми нужна и за напред! Има неща, които се надявам да променим и доизгладим, за да можем да работим ефективно и в помощ на семействата! Но и това с времето! Към момента всичките ни семейства са със стар тирали процедури и мо жем да им пожелаем само късмет и скоро да гуш нат така бленуваните рожби! З а какво мечтаеш днес? За какво мечтая ли? Всич ките ми деца да са живи и здрави и да няма семей ство без рожба. Децата ни да растат под ясно и мирно небе в прекрасната ни Родина, да бъдат гор ди Българи и да ни има! Но най-вече – да бъдем Чо веци!
ъм какво си непри мирима? Към неправдата. На мо менти съм си мислила, че ако мога да замълча, ще бъде друго. Но пусто сър це не търпи. Към алчност
12 І БРОЙ 18
К

13 БРОЙ 18 І та – колко му трябва на човек и за какво?! Към дву личието – кому е нужно?! П овече мечтател или повече реалист си в живота? Повече реалист, по-малко мечтател. К ак презареждаш батериите? С пътуване – човекът е човек, когато е на път! Със срещи с приятели. С Радмил и Борил. Аааа, заб равих
У
Да
ци!
на хора та – да ги посрещат и из пращат с усмивка и добра дума, нищо не струва! Да не се отказват никога и пред нищо! Няма невъз можни неща. С едно изречение –твоето послание към двойките с репродуктивни проблеми като „рецепта за бебе“? Не е успял само този, кой то се е отказал! Няма невъзможни неща, ня кои искат просто пове че време.
– и на буките в Трънско с Шарки.
роците, на които искаш да научиш Радмил и Борил?
бъдат най-вече Чове
Да помагат
„Бъдете доБри!“
Блага Димитрова е на 28 го дини. По образование е ма гистър „Финанси“, а в профе сионален план е „Специалист финансови продукти юриди чески лица“. Другата й профе сионална страст е работата като гримьор. Блага обожава планинските преходи, българските народ ни танци, както е и изключи телна в създаването на деко рации за дома и събития. Интересува се от холистич на медицина, основана на раз бирането, че умът, тялото, духът, емоциите, социалните фактори и околната среда са взаимносвързани.


Блага, много ми се иска да ни раз кажеш за твои силни моменти от детството. Какво дете беше? Кое е най-запомнящото нещо от родителите ти? Имах едно прекрасно детство, макар и да бях много болнаво дете. Бях спокойна, ученолю бива и обичах да се забавлявам. Израснах на село, близо до гр. София, което ми позволи да имам детство, изпълнено с игри и приключе ния! Може би най-запомнящото е това да се борим винаги и да не се предаваме, каквото и да става! Как протича един твой ден днес –с какво се занимаваш? Само по този въпрос може да напишем цяла статия. Дните ми са много динамични – рабо тя във финансова институция, работя като професионален гримьор, виждам се с прияте ли, във всеки удобен момент отивам в пла нината. Преди операциите танцувах българ ски народни танци и планирам подновяване на това забавление. Имах мечта, която осъщест вих преди около месец – да поседт най-извест ния български фертивал в с. Жеравна! Неза менимо изживяване, което те пренася в един магичен свят!
действия веднага. През месец март 2020 г. предстоеше годишният ми про филактичен преглед. Месец февруари започнах да усещам тялото си по-различно – изпитвах
14 І БРОЙ 18
Как се случи твоята среща с рака? Как го откри? През месец октомври 2019 г. напипах образува ние в лява млечна жлеза по време на душ. Тога ва бях на 25 години. Не съм и предполагала, че може да бъде карцином. Поради тази причи на, не предприех
СИЛА ЗА ЖИВОТ
затруднения със събужда нето сутрин, имах доста неприятна миризма при изпотяване. Това ме нака ра да потърся медицинско мнение по-рано. През какво премина и как оценяваш преживяното към днешна дата? Преминах през различни ле кари и три държави. Опе рираха ме първоначално с цел премахване на об разуванието, а когато се
събудих – нямах и лимф ни възли и чух диагнозата: „Имаш рак, но спокойно, имаш късмет – не е най-аг ресивният”. За съжаление, докторката нямаше чис ти намерения, държеше се арогантно с всички, без да отговаря на въпроси и да дава напътствия. Това ме накара да потърся друг ле кар и качествена информа ция какво да правя. По мое решение, избрах да ми бъде направена едноетапна двустранна мастектомия
от д-р Красимир Шопов. Добър доктор и човек – бе до мен през цялото време, обсъждахме всичко, което ме притеснява, за което
му благодаря изключител но много! Пътят не е нито лесен, нито кратък, но и това ще мине, стига да вярваме и да го искаме!

Иска ми се да на чертаем заедно сега пътя на една жена, която е диагностицирана с рак на гърдата. Откъде се тръгва? След ехограф и съмнение за злокачествен процес, задължително трябва да бъде предприета КОР би опсия или т.нар. широко иглена биосия. Благодаре ние на нея, патолозите могат да определят с точност типа на тумора и по този начин да бъдат предприети адекватни мерки – дали да се започне с лечение или с операция. Освен биопсията, е необ ходимо да се направи об разно изследване, с което да се установи, заболява нето в какъв стадий е и дали има близки и/или да

15 БРОЙ 18 І „БЪДЕТЕ ДОБРИ!“
лечни метастази. След това започва съв купната работа с докто рите и това да бъде ре шено, кое е най-добре и подходящо за жената в текущия момент и за бъ дещето й.
Кои са „малките камъчета“, които могат да спънат по пътя към лечението?
Според мен пътят може и да е по-труден, когато не можеш да намериш лекар, на когото да се довериш. Друго много важно е бо лестта да започне да се диагностицира предимно в ранен стадий – по този начин пациентът ще има по-голяма надежда и сила в себе си. Как се случи срещата ти с „ИСКАМ БЕБЕ“ и могат ли замразените яйцеклетки да те накарат да преминеш с повече надежда през болес тта? През 2017 г. се включих като доброволец в НПО „Движение за национал на кауза“, създадено по идея на водещия и проду цент Андрей Арнаудов с цел привличане на внима нието на хората към про блемите, свързани с демо

16 І БРОЙ 18
СИЛА ЗА ЖИВОТ
графската криза у нас. Там се запознах с невероятна та Моника Иванчовска –двигател на организация та, и след провеждането на второто национално масово кръщене се запоз нах с Радина Велчева, съз дател на фондация „Ис кам бебе“. За нея думите са малко – Човек, жена, бла гословия! Благодарение на тях, започнах проследява не при д-р Георги Стаме нов. Последните две го дини и половина преминах през две операции за пре махване на ендометриозни кисти, отстраняване на полип на матката и проце дура по замразяване на яй цеклетки! Изключително благодарна съм на д-р Ста менов за неговия профе сионализъм и отношение. През цялото това време той запази яйчниците ми и успя да извади 13 годни за замразяване яйцеклетки. Това беше изключително важно за мен, защото все още нямам деца, по този начин мога да бъда по-спо койна. Също е важно да отбележа, че при доказано онкологично заболяване, процедурата може да бъде поета от фонд и съвет вам дамите да се поинте ресуват как може да ста не това. Откъде дойде страстта ти към

грима? И как ти, през погледа на 28-годишно момиче, разбираш женската красота? Са мата ти искаш ли да „гримираш“ по друг начин твоите „белези“ от битката ти за живот“? Още от дете, както по вечето малки момиченца, така и аз обичах да се гри мирам и разкрасявам дру гите. През времето, ко гато бях в болничен и се бях възстановила от опе рациите, записах и завър ших курс за професионален гримьор. Не възприемам преживяното като битка и не се чувствам „победи тел“. Това е част от пътя ми на земята, преминал и събудил още по-силно едно чувство в мен – да пома гам на другите! Да вярват в себе си и да им покажа колко са красиви и значими, където и да се намират
година да посещават про филактични прегледи. Също така, бъдете добри – направете нещо мило и помогнете на някого, дори и непознат. Тази добри на ще бъде възнаградена в точния момент!
За какво мечтаеш днес? Мечтая да няма болни и самотни хора, да виждам усмивки на лицата и да има щастие и любов в сър цата!
Към какво си непримирима? Непримирима съм към лошо поведение и отно шение, както и към това лекари да те гледат като „касичка“ и въпреки това, отново да не получаваш необходимите грижи.
Твоята лична молитва за България? Господи, Боже наш, Ти, кой то бдиш над света, чуй молитвата ми, озари ни с лъча на могъщия Си Дух и разпали в сърцата ни ис крата, която си вложил в нас. Благодаря Ти за Любо вта, с която Си ни изпъл нил. Просвети ни да бъдем смели и доблестни бъл гари. Дай ни сила и здра ве да живеем, да работим за благото и величието на Отечеството ни. Благода ря. Да бъде!
17 БРОЙ 18 І
Самата
зираш
готворителни
бития,
помагаш
с
на
Какви са твоите послания към цялото ни общество? Едно от най-важните пос лания е да не пренебрег ват здравето си
те по пътя си!
ти органи -
много бла
съ -
чрез които
на жени
рак
гърдата.
и всяка
„БЪДЕТЕ ДОБРИ!“
една от първите, които развиват съхранението на стволови клетки с най-съвременните и надеждни мето ди и технологии. Стартирала своята дейност през 2005 г., биобанката е единствена в България, която осъщест вява дейност и в областта на фамилно стволовокле тъчно банкиране и тъканно банкиране при донорство. Целта на банката е по-добра достъпност на високо технологични услуги за българските семейства, по-ви соко качество на донорски материал за транспланта ции, повишаване на информираността на обществото по въпросите на донорството и новите медицински по стижения в областта на трансплантациите и регенера
тивната медицина. „Биорегенерация“ разполага със собствени високотехно логични лаборатории и обучени специалисти, за извърш ване и подсигуряване на всеки един от етапите по взе мане, обработка и съхранение на стволовите клетки. Стволовите клетки от десетилетия лекуват и спася ват живот заради уникалната им способност да се въз произвеждат и превръщат в различни типове специали зирани клетки. ТБ „Биорегенерация“ предлага извличане, обработка и съхранение на стволови клетки от пъпна връв и от пул па на млечен зъб.
18 І БРОЙ 18 Как да се възползваме от услугите на банката или как да съхраним стволови клетки: За да заявите желанието си за съхранение на стволови клетки или да получите повече информация, трябва да постъпите по следния начин: 1. Да се свържете с нас на посочените координати. 2. Да получите пакета документи от нас, с който да се запознаете. 3. Да подпишете договор с нас възможно най-рано, преди да настъ пи моментът на раждането (задължително трябва да имаме по дписан договор преди раждането). 4. Да ни уведомите на спешната линия, когато започне раждането. ЖИВОТЪТ Е БЕЗЦЕНЕН! „Биорегенерация“ е най-голямата българска тъканна бан ка и
БИОРЕГЕНЕРАЦИЯ: ЖИВОТЪТ Е БЕЗЦЕНЕН

19 БРОЙ 18 І Координати на ТБ „Биорегенерация“: → Тел: 0882 373 318 → e-mail: office@bioregeneration.bg www.stvolovikletki.com и www.bioregeneration.bg → Адрес: 1330 София, район „Красна поляна“ ул. „Блага вест“ 3, сградата на МБАЛ „Надежда“ 1407 София, МОЛ „Парадайс“, етаж 3 до МЦ „Надежда“ ЦЕНИ: Договор БИОСЕЛ ПЛЮС – 5500 лв. - Съхранение на 2 вида стволови клетки – хемопоетич ни и мезенхимни стволови клетки - Период на съхранение – 20 години - Има възможност за разсрочено
Договор БИОСЕЛ –
-
-
на съхранение – 20 години - Има възможност за разсрочено плащане и отстъпки Договор БИОКОРД – 3300 лв. - Съхранение на 1 вид стволови клетки – мезенхимни стволови клетки - Период на съхранение – 20 години - Има възможност за разсрочено плащане и отстъпки Договор БИОДЕНТ – 2300 лв. - Съхранение на 1 вид стволови клетки – мезенхимни стволови клетки от пулпа на млечен зъб - Период на съхранение – 20 години - Има възможност за разсрочено плащане и отстъпки
плащане и отстъпки
4700 лв.
Съхранение на 1 вид стволови клетки – хемопоетични стволови клетки
Период
Специалист по репродук тивно здраве. Специализирал е в един от най-големите лапароскопски ин ститути в света – IRCAD. Трето по коление потомствен лекар и част от структурата на специализираната университетска болница „Селена“ в Пловдив. Д-р Даниел Ставрев е първият бъл гарски лекар, който завършва невро пелвиология. По време на една опе рация, проф. Марк Посовър, който е един от основните вдъхновите ли на д-р Ставрев, докосва с биполя рен ток основен нерв на крака и виж
да, че кракът помръдва. Нищо ново, виждано е множество пъти. Проф. Посовър обаче се досетил, че ако този нерв се стимулира с подходящ електрод, може да възвърне функци ята си. В момента професорът, пос ветил работата си на това да по добрява качеството на живот на хората, има десетки пациенти, с оп ределени двигателни проблеми, кои то е изправил на крака. Вследствие на многогодишна научна и хирурги ческа работа и на богат клиничен опит, е поставено началото на дис циплина и хирургическа платформа, която отваря „врати към нова земя“ и възможности за лечение – невро пелвиологията.
Нова област Невропелвиологията е нова област в тазовата хирургия. Нова медицин ска наука, фокусирана върху пато логиите, засягащи тазовата нерв на система, с основен фокус върху хроничната тазова болка и възмож ностите за подобряване на диаг ностиката й. Това е един проблем, за който почти не се говори заради сложната диагностика, обхващаща много други специалности в медици ната. Невропелвиологията може да помогне на много жени да подобрят качеството си на живот. Тази дисци
плина предлага удивителни възмож ности за моделиране и възстановя ване на невроналната функция. Поради нарастващия интерес в ме дицинската общност към темата, през 2014 г. е основано Международ ното дружество по невропелвео логия. Обичайната практика в гине кологичната хирургия рядко обръща внимание на тазовите нерви, което ограничава знанието за тях. От съз даването на Дружеството, ново

20 І БРОЙ 18 ИНОВАЦИИ В МЕДИЦИНАТА НЕВРОПЕЛВИОЛОГИЯТА –
ТАЗОВАТА
НАДЕЖДА ЗА ЛЕЧЕНИЕ НА
БОЛКА
възникналата дисциплина набира все по-широка популярност и интере сът към нея непрекъснато расте. Д-р Даниел Ставрев
е акушер-гинеко лог с фокус в областта на оператив ната гинекология и ендоскопските операции.
кретни заболявания, увреждащи нервите в малкия таз. Хроничната тазова болка (Chronic pelvic pain – CPP) е често срещано състояние, включващо множество медицински специалности, всяка от които със свой собствен под ход за диагностика и лечение. Упра влението върху хроничната тазова болка изисква познаване на взаимо действието между функциите на тазовите органи и неврофункцио налната тазова анатомия, както и на неврологичните и психологически те аспекти на пациента. Дефинира ме хроничната тазова болка като незлокачествена болка. Отрицател ните когнитивни, поведенчески, сек суални или емоционални последици и нарушеното качество на живот са най-честите проблеми на пациенти те с тази диагноза. Когато болката продължава повече от 6 месеца след елиминирането на първоначалната етиологична причина, или когато не е открита причина за наличието на дискомфорта, се смята, че се е раз вил синдром на хронична тазова бол ка. Той се среща при между 4 и 15% от
пациентите. Заболяванията, които попадат в спектъра на невропелвеологичното обследване, включващи хроничната тазова болка, са: • Ендометриоза, засягаща директно тазовите нерви • Хронична уринарна дисфункция (спастичност, болка при уриниране)

• Ретенция на урина (представлява невъзмож¬ност на пациента да ури нира, въпреки че пикочният мехур е изпълнен с урина), фекална инконти ненция (трудността при контроли ране на задържането на фекалии и чревни газове).
• Невропатична тазова болка – мо ноневропатии (напр. пудендална не вралгия). Това състояние включва
симптоми като: болка – обикновено едностранна, силна или пареща, съ четана със сексуална дисфункция. • Парестетична мералгия (Meralgia Paresthetica) или т.нар „синдром на Бърнард-Рот“ е болезнено състоя ние, свързано с притискането или увреждането на бедрения кожен нерв (nervus cutaneus femoris lateralis). Заболяването се среща по-често при жените и при пациенти със заха рен диабет, като в около 25% от слу чаите може да засегне и двата край ника. Пациентите се оплакват от тъпа болка, парене, изтръпване или мравучкане в предната и външна та част на бедрото и от дисфунк ция на генитофеморалния нерв. Най-честите причини за възниква нето на парастетичната мерал гия са състояния като: затлъстя ване, бременност, асцит, сколиоза. Други възможни причини са – нервна
21 БРОЙ 18 І НЕВРОПЕЛВИОЛОГИЯТА – НАДЕЖДА ЗА ЛЕЧЕНИЕ НА ТАЗОВАТА БОЛКА Задълбочени познания Невропелвеологията предоста вя на гинеколозите задълбочени познания в областта на анато мията на тазовите нерви, което увеличава шансовете за успешно справяне с патологии, свързани с тях. Дисциплината задълбочава познанията ни за прилагането на безопасна хирургия, щадяща нервите. Учи ни как да разпознава ме и управляваме увреждането на нервите и ни дава безопасни, из
подходи за справяне
кон
питани
с
дисфункция вследствие на диабет, хипотиреоидизъм или алкохолно от равяне, поради дефицит на витамин В12 или фолиева киселина. • Параплегията представлява фор ма на частична парализа, при коя то може да се установи загуба на се тивност за болка и температура. Също така е възпрепятствано дви жението на долните крайници. Може да се установи и парализа на пикоч ния мехур и червата. • Основната причина за развитие на хронична тазова болка е ендоме триозата. Това е хронично гинеколо гично заболяване, което засяга око ло 200 милиона жени по целия свят. Една от десет у нас на възраст меж ду 15 и 44 години е с ендометриоза. Това е състояние, при което клетки, подобни на тези на ендометриума (лигавицата на матката), се разпрос траняват извън матката. Най-чес то тъканта обхваща яйчниците, фа лопиевите тръби или други органи в таза и причинява хронично тазова болка и безплодие. Въпреки че заболя ването е често срещано, информа цията за него е ограничена, а диагно стицирането му – трудно.
определяне на причината за хроничната тазова болка следваме три стъпки: Първо и много важно е да се сне ме анамнеза на пациента с фокус не само върху локализацията на болка та, но и върху историята на болка та, ирадиацията (излъчване на бол ката от едно място към друго), придружаващите фактори, вредни те навици, вегетативните и сома тичните симптоми. След това се определя потенциалната етиология в съответната анатомична област. Свалянето на анамнезата на пациен та отнема много време, но в повече то случаи дава възможност за уста новяване на вероятната диагноза, която може да бъде потвърдена или отхвърлена от клиничния преглед. Втората стъпка се основава на кли ничен преглед и сонография (УЗИ –ултразвуково изследване), както и













22 І БРОЙ 18
Типове ендометриоза Ендометриозата може да бъде класифицирана в 3 различни типа: 1) Повърхностна перитонеална ендометриоза. 2) Ендометриозни кисти на яй чниците, т.нар. „Шоколадови кисти“. 3) Дълбоко инфилтративна ендометриоза (DIE). За щастие, най-често срещана та разновидност е повърхност ната перитонеална ендометриоза. Дълбоко инфилтративната еднометриоза може да бъде из ключително агресивна и да се разпространи в съседни тазови органи, включително черва, пикочен мехур и уретери. Може също така да обхване тазовите нерви, които инервират вътрешни ор гани и скелетните мускули в малкия таз и долните крайници. За
ИНОВАЦИИ В МЕДИЦИНАТА
ядрено-магнитен резонанс (MRI). Третата тръпка включва лапаро скопско изследване на тазовата ку хина за потвърждаване и лечение на предполагаемата причина. Невропелвеологичният подход към хроничната тазова болка е предим но диагностичен с прилагането на неврологични принципи и познания за неврофункционалната анатомия на таза. От съществено значение е да се различи дали болката е висцерална или соматична. Висцералната болка в долната част на корема се раз пространява чрез хипогастралния сплит и може да бъде разпозната по ради дифузния си характер. В опре делени случаи може да ирадиира към гърба, бивайки придружена от мно жество вегетативни симптоми като неразположение, краткотрайна загуба на съзнание (синкоп), раздраз нителност, подуване на корема, га дене, повръщане и умора. Соматичната болка се локализира върху повърх ността на кожата и се описва като алодиния или като удар от електри чески ток. Тя е със специфична ло кализация в областта около опаш ната кост с разпространение към
бо-сакралния плексус. Това помага за по-лесното и коректно диагности циране на неизвестните досега ло кални причини за соматична тазова болка, причинена от сраствания или фиброза в резултат на предходна оперативна интервенция, както и нервна декомпресия или невролиза.
Схемата за невропелвеологична обработка следва следните шест стъпки: 1. Определяне на нервните пътища, участващи в предаването на инфор мация за болка към мозъка. Ингвинал но-коремната болка, разпространя ваща се към долната част на корема и гениталната област, е свързана с патологията на нервните окон чания, произхождащи от лумбалния плексус. Генито-аналната или пуден далната, кокцигеална и тазова болка с каудална ирадиация е свързана с па тология на плексус сакралис или не говите нервни клонове, като глуте ални или пудендални нерви.
2. Определяне на местоположение то на неврологичното дразнене.
3. Определяне на вида на лезията на нерва, дразнене при нараняване.
4. Неврологично потвърждение на предварителната диагноза чрез клиничен преглед или по-специално трансвагинална или трансректална палпация на тазовите нерви.
в коремната кухина
перитонеума) с достъп до лум



5. Определяне на потенциална ети ология въз основа на анамнеза на па циента, клиничния преглед и образ ното диагностично изследване (MRI). 6. Насочена терапия към съответ ната етиология – предполагаемата причина и предложение за съответ

23 БРОЙ 18 І
гетативни
то
лапароскопската
се дава възможност
то на ретроперитонеалното
во пространство (анатомичното
генитално-аналната област или до лните крайници. При нея липсват ве
симптоми. С развитие
на
хирургия
за изследване
тазо
пространство
зад
НЕВРОПЕЛВИОЛОГИЯТА – НАДЕЖДА ЗА ЛЕЧЕНИЕ НА ТАЗОВАТА БОЛКА
но лечение. В много от тези случаи може да се постави етиологична ди агноза и да се започне правилно ле чение. При лечението на пациенти с хронична тазова болест са необхо дими нови изследвания и съвременни стратегии за диагноза и лечение. Диагностичният етап използва собствени подходи и от особено ва жно значение е анамнезата на паци ента. Тя обхваща много аспекти от гинекологията, урологията, ортопе дията, патология на тазовите съ дове и психологията на пациент с хронична тазова болка. Клинични ят преглед включва ехографско из следване на органите, разположени в малкия таз, неврологично изследване на опорно-двигателния апарат с не вропелвеологично изследване и пал пацията на тазовите нерви по ваги нален или ректален път. След внимателно поставяне на ди агнозата, следва лечение на хронич ната тазова болка с конкретни нови техники, основаващи се изцяло на ла
пароскопската хирургия, включващи декомпресия и невролиза на тазови
те нерви.
Един от възможните методи за ле чение на дисфункциите на тазовите органи е чрез терапия за стимулира не на гениталните нерви. Стиму лирането на вегетативната нерв на система на таза пък е подходящо за превенция или лечение на меди цински състояния като остеопоро за и някои сърдечно-съдови заболява ния. Проследяването на пациентите след проведена терапия за лечение на хроничната тазова болка е от съ ществено значение. След извършена лапароскопска декомпресия на нерв, невропатичната болка първоначал но значително се увеличава, а подо брението обикновено настъпва едва осем-десет месеца след операцията. Проследяването
пациенти с хронична тазова болка, при които има увреждане на нервите и дисфункции на тазовите органи. Тя може да позволи на бол ката да бъде контролирана, успо редно с невромодулацията в други периферни нерви. Най-впечатляващата индикация за използването на посочената техника е импланти рането на невропротеза при хора с наранявания на гръбначния мозък. Протезата изцяло възстановява

24 І БРОЙ 18
на тези пациенти е от съществено значение, за да се ко ригира медицинското лечение и да се лекува „паметта“ на болката
но
Последното обаче е много
Процедурата LION Иновативната процедура LION е техника за лапароскопско имплан тиране на невропротеза на тазовите нерви. При тази съвременна процедура, насочена главно към па циенти с хронична тазова болка, ен доскопският подход позволява при аксонална лезия или дисфункция на тазовите нерви да се извърши се лективна лапароскопска имплан тация на невропротеза (LION про цедура), чрез която се извършва електрическа стимулация на засегнатите нерви в малкия таз. Тази процедура се използва за лечение при
2006 г. при пациент с параплегия за контрол на функцията на пикочния мехур. Тази иновативна невропелвеологична процеду ра с фокус към хроничната тазова болка трябва да бъде извършена от опитни хирурзи със специално обучение по лапароскопска тазова хи рургия. Материалът е публикуван с подкрепа та на „Мерк България“. BG-NONF-00074/септември 2022 ИНОВАЦИИ В МЕДИЦИНАТА
възмож
най-успешно.
по-трудно за постигане.
някои функции при ходене. Първата LION процедура е извърше на успешно през


26 І БРОЙ 18
Ние с ъздава ме Вашето бъдещ е!
МЦ „Репробиомед“:

27 БРОЙ 18 І Съ з даде н пр е з 1999 г. о т д р Павле т а Таб аков а и д о ц . д р И ва н Н и коло в, Мед и ц и н ск и це н т ър „Репр о б и о м е д“ п о в еч е о т 20 го д ин и дав а р е ш е н и е н а д в ой к и т е с р епр о дук т и в н и п р о бле м и П р и н ас ще ср е щ н е т е в и со кокв а ли ф и ц и ра н е к и п с п р и я т елско о т н о ш е н и е П р и лаг а м е н ай м о д е р ни т е, еф е к т и в н и м ет од и и т ехн и к и з а уст а н о вя ва н е и леч е н и е н а б е з п лод и е т о: Д р Ге о рг и Н и коло в: В М Ц „Реп роби о м ед“ д войки т е п олуч а ва т п ъл н о обс лу ж ва н е о т д и агн ости ц и ра н ет о д о ра жд а н ет о и с лед т ова, за щ о т о н и е см е се п ос вет и ли д а с ъ зд а ва м е Ва ш ет о б ъд ещ е! Д р Гео рги Н и колов, а к уш ер ги н еколог, р ъковод и т ел Сек то р „ Асист и ра н а реп родукц и я “ • Прециз на хормона лна и обра з на диагностика (4D ехография) • Ге н е т ич н и и и мун олог ич н и и з с ле д в а н и я • П ълн а г а м а о т аси ст и ра н и репр о дук т ив н и т ехн олог и и (и н в и т р о о п ложда н е; IC SI; P GS/P G D; tim e-lapse к улт и в и р а н е; вът р е м а т оч н и и н се м и н ац и и; д он о р ска к р и оба н ка , R I Witnes s еле к т р о н н а си сте м а з а м акси м а ле н ко н т р ол и си гурн о ст н а в аши т е е м б р и о н и; м ин и м а лн о и н в а з и в н и хи рур г ич н и т ехн ик и – ла паро ско п и я и хи ст е ро скоп и я) • П р о с ле д я ва н е н а р и сков а б ре м е н н о ст и р а жда н е Оч акв ай т е: Ин д и в и дуа ле н п о дхо д В н и м а н и е к ъ м де т ай ли т е Д ългогод и ш е н о п и т с н ай т руд ни т е с лу ч аи в р е про дук т ив н а т а м е д и ц и н а Ава н г ар д н и м е то д и з а леч е н и е н а б е з п лод и е т о
Момичетата от града: Кога спираме да се влияем от стереотипите за красотата и перфект ните мерки и започваме да се приемаме такива, каквито сме? Радина: Мисля, че това е процес. Случва се посте пенно, точно с темпото на емоционалното ни по растване. Резките движе ния не водят до качест вено порастване в това отношение. Няма нищо странно в това, че огле далото е вечният жен ски спътник. Но с години те започваме да виждаме различно женско „Аз“: мал ките бръчки около очите, всъщност, стават белег за моментите, в които сме били истински щаст ливи.
НЕЩАТА ОТ ЖИВОТА

33 кожата ми започна да се съобразява с темпото ми на живот и с емоциите ми. Чувствата и мечтите ми започнаха да се надпре варват с времето. На гости на „МОМИЧЕТАТА ОТ ГРАДА“, с които споделяме красотата във всичките й форми.
Момичетата от града: Повлиявали ли сте се някога от тези стере отипи?
Радина: Няма нищо „нечо вешко“ в това да си под
влияние на различни сте реотипи. Днес мога да кажа, че като погледна 30 години назад и спра погле да си в моите 18, забеляз вам сякаш цикличност в тези стериотипи. Често като се прибирам в родния си Добрич и отворя ста рите гардероби, въобще не мисля, че нещо е толко ва остаряло, че да не може да понесе още живот днес. Зависи от цветовете, с които багрим деня си, от ношенията си, мечтите за утре...

28 І БРОЙ 18
СПОДЕЛЕНО ОТ „ОСЪНОВЕНИТЕ АНГЕЛИ“
Момичетата от града: Вие, самата, кога започ нахте да се чувствате добре в кожата си? Радина: След като навър ших 33. Странно е, но днес като гледам снимките си отпреди тази възраст, естествено е да виждам младостта във всички те й измерения – свободен дух, търсещ поглед, тъга и отчаяние, радост и без грижие. Но всъщност, след Започ нах да търся истинската стойност на нещата, кои то правя, и какво е оно ва, което ме прави жива. Кое е онова нещо, което ти дава отговор на ве
чния въпрос: „И какво от това?!“.
Момичетата от града: Кога една жена е истински красива? Радина: Когато прелива от щастие. Когато се чув ства необходима, завър шена и споделена. Когато има с кого да изпие чаша вино и да се смее до полу да. Когато има при кого да се завърне, ако е изгубила пътя. Когато парфюмът й се слива с уханието на лю бимо същество и усеща приемането във всичките му форми.
Момичетата от града: Какво не ни достига по някога, за да видим кра сотата около себе си? Радина: Силата да про меним нагласите си и да сменим гледната точка. С годините разбирам, че единственото ни спасе ние в моментите на про падане е да не спираме да вървим към вътрешното си „нагоре“. Отвисоко про блемите ни придобиват друг вид – можем да ги ви дим като мънички точи ци, които имат нужда от пренареждане. Едни ще се търкулнат в ниското и ще се отървем от тях за винаги, други ще сменят местата си и ще разбе рем, че така е по-добре, а трети ще ни бъдат път
ните знаци за следващото стъпало.
Момичетата от града: Много бебета са се родили благодарение на кампаниите на вашата фондация „Искам бебе“, Вие самата сте вдъхно вител за много бъдещи майки. Но има ли момен ти, когато историите, с които сте се сблъсквали, са вдъхновявали Вас, давали са Ви сили? Радина: „Искам бебе“ е мо ята визия за женска кра сота. За мен, лично, няма по-красива жена от тази, която осъзнато иска да стане майка. Стремежът към детето пречист ва както емоциите, така и лицето ни, преподреж да вътрешния ни баланс и дрехите в гардероба, из хвърля затлачените стра хове и фалшивите хора от живота ни. И всичко това прави път на новото, на Детето. Момичетата от града: Миналата седмица се появи коментар във воде ща медия, че „абортът е убийство“. Защо, според Вас, изобщо се стигна до него и редно ли е една жена да изгуби правото си на такъв? Радина: Това е един от ве чните въпроси на човеш кия род. Има много тъл
кувания, цели философски школи са разисквали раз лични казуси, касаещи аборта. Мисля, че това е така, защото в основата на решението за аборт е мотивът, с който е заче нат един човешки живот. Ако абортът е убийство, то как да оценим зачена тия живот след изнасил ване или друга външна

29 БРОЙ 18 І НЕЩАТА ОТ ЖИВОТА
агресивна намеса на обще ството върху женското тяло или психика? За мен, лично, един живот е по-си лен от всичкото зло и ако едно дете трябва да се роди, то намира начин и сила да стори това. Това е една от големите тай ни на Вселената ни. Защо например една жена пра ви десетки опити да заб ременее и не успява, а дру ги правят поредния аборт и след година-две раждат живо и здраво дете?! Кои сме ние, че да отсъжда ме кой живот е по-ценен? Пък, ако си правила аборт, да бъдеш проклета от об ществото ли? Чувство то за вина може да се ока же най-тежкият камък на шията за една жена, коя то не

калява силата си да взе ма решения за бъдещето си, както и да носи послед ствията от този избор. А силата на едно общество се измерва в умението да приемеш изборите на се беподобните си, а не да ги осъждаш. Момичетата от града: Преминали сте през редица неуспешни опити за забременяване. Кога ре шихте, че трябва да се даде гласност на пробле ма за безплодието? Радина: Никога не съм кри ла проблема си. Напро тив, споделяла съм го още от самото начало. Ми сля, че хората с репродук тивни проблеми сме мно го по-готови да говорим за предизвикателство то „безплодие“, отколко то обществото може да ни чуе.
Момичетата от града: Какво Ви даваше на вас сила по време на този път? Радина: Вярата, че вървя по моя си път. Когато си в своя си път, всичко око ло теб става по-красиво и ясно. Аз се променях към добро, откривах неподо зирани качества за себе си. Така вярата ме водеше в този различен и труден, но МОЙ си път. Знаех, че ще стана майка и просто ис ках да намеря верния път към МОИТЕ си деца.
Момичетата от града: Доколко е важна подкрепата на околните в тези моменти и на Вас кой би беше най-голяма та опора? Радина: Подкрепата на близките ти е от ключо во значение, но за да я оце ниш, ти трябва да я поис каш сам. Тогава формулата за подкрепата започва да работи на пълни обороти. Непоисканата подкрепа от когото и да е просто не може да сработи. Моя та благодарност е преди всичко към съпруга ми Бо жидар, който изтърпя бо шуващите ми хормони в годините, а днес е най-пре красният баща за двете ни деца. Огромна благосло вия е да имаш и родители като моите мама и татко, които нито веднъж не ме

30 І БРОЙ 18 СПОДЕЛЕНО ОТ „ОСЪНОВЕНИТЕ АНГЕЛИ“
се е подчинила на обстоятелствата в ня какъв момент. Затова
сля, че една жена
ми
трябва да
то, когато вече сме били готови да го приемем с цялата си същност. За това решение никога не знаеш кога е точно време
то. При нас не беше 50 на 50! Беше най-сигурното нещо, което в този мо мент искаме и двамата. Не беше компромис, нито спасение от депресия или търсене на път в задъне на улица. Според мен ре шението

31 БРОЙ 18 І НЕЩАТА ОТ ЖИВОТА
за осиновяване не е свързано с броя на не успешните опити инви
упрекнаха за нищо, а тър пеливо ми изпращаха от неземната си обич и под крепа. Момичетата от града: Казват, че решението за осиновяване на дете не трябва да дойде след последния неуспешен опит инвитро. Вие как стигнахте до това ре шение? Радина: Решението за осиновяването при нас дойде точно във време съ вършени създания и един ственото нещо, в което съм сигурна, е, че те изби рат нас.
тро, а с момента, в кой то усетиш, че сърцето ти е в хармония с пред стоящото очакване. Това е моментът, в който усе щаш лекота, даваш по чивка на сетивата си, не бързаш заникъде, умора та изчезва от плещите ти и просто оставяш Бог да се погрижи да идващо то раждане. Децата са
Момичетата от града: Какво беше усещането след толкова години и неуспешни опити за заб ременяване най-после да прегърнете децата си –Вашата дъщеря Йоанна и сина Ви Симеон? Радина: Осъзнах, че живо тът може да започне от ново точно на 40! Тогава се намерихме с къдрокосо то съвършенство Йоан на. А на 45 житейското ко лело отново се превъртя и в дома ни кацна синеоко то щастие Симеон. Така прегръдката ми вече има точни измерения – точ но толкова, че да побира и двамата, сгушени в ску та ми. Може би това е усе щането, по което си при личаме всички жени, които жадуваме да станем майки! Момичетата от града: Какво бихте казали на момичетата, които искат бебе, но в момента преминават през същи те трудности, през кои то и Вие сте минали? Радина: Искам да ги пока ня на гости и да чуят как Йоанна разказва нейната си приказка за майките и бебетата. И тази приказ ка винаги завършва така: „Ако не може едно бебе да се роди от корема, то се ражда от сърцето, и го тово. Така семейството заживяло щастливо!“.
Д-Р СЪБИНА ПЕРСЕНСКА: „ВИЕ МЕ КАРАТЕ ДА ИСКАМ ДА БЪДА МЕЧТАТЕЛ!“
приятели! Аз съм Юлия Живкова – координатор на фондация „Искам бебе” за кампанията „От бебе за бебе”,
ще
ви разказвам за нашата кауза, дарители и съмишленици. Ще споделям с вас за нашите инициативи и базари, за това как ние, майките, вече сбъднали мечтата си за рожба, помагаме на двойки с репродуктивни проблеми и пациенти на д-р Персенска в борбата за дете! Предстои ви да се срещнете отново с любимата ни д-р Персенска – но този път извън кабине та и в малко по-различна роля. Перси – както често я наричаме всички ние, докоснали се до ней ната душа – разказва пред читателите на списанието ни, за детството и мечтите си. Иначе, за тези, които тепърва ще се срещат с този уникален лекар и човек, ще кажем, че тя е специалист по репродуктивна медицина. Работи в МБАЛ „Надежда“ и благодарение на нея са се родили хиляди желани деца!
Д-р Персенска, какво дете бяхте и кои са най-ярките спомени от детството Ви? Послушно и кротко, мисля. Спомням си, че майка ми ми възлагаше доста неща да върша. Най-ярките ми спо мени, които и до днес не са избледне ли, е как веднъж изгубих брат си, до като майка ми ми го беше поверила за няколко часа. И другото нещо, което няма да забравя, е как майка ми ме пре следва с таблицата за умножение.
се върнете години назад, би хте ли заменили лекарската

фесия с друга?
казвам,че
нещо по-спокойно и ненато варено с толкова отговорност и
32 І БРОЙ 18
ОТ БЕБЕ ЗА БЕБЕ
Д-р Персенска завършва медицина в София и специализация по „Акушерство и гинекология“ в „Майчин дом“. Професионалните й интереси са насочени към асистирана та репродукция, диагностиката и лечение то на безплодието. Д-р Персенска е отличен хирург. Визитка
Ако
про
Понякога си
е трябвало да избера
Здравейте,
и
продължавам да
стрес. Замисляйки се обаче, не мога да се сетя какво друго бих могла да върша. Разбира се, от днешна гледна точка, така че май не бих я заменила. Смятам, че освен чисто медицинска та част, тази професия разширява много повече светогледа на човек и го кара да се замисли и оцени истин ските неща в живота. Повече мечтател или повече реа лист сте в живота? Определено съм повече реалист! Жи вотът ме научи да не храня излиш ни надежди и да нямам илюзии по от ношение на нещата. Рядко се случва да ме изненада нещо толкова нео чаквано. Невероятно и неочаквано Между другото, появата на група та „От бебе за бебе” е за мен нещо наистина невероятно и неочаква но. Бях много приятно изненадана, че толкова хора с такъв ентусиа зъм вършат нещо наистина стой ностно за други, съвсем непознати хора. Когато се сетя за всички тях – Радина Велчева, която не спи ра да помага и да мисли за хората, Юлето Живкова, която е неспирен
Толкова много хора се бяха събрали и дойдоха да ме поздравят в болница та по случай рождения ми ден. Опре делено дотогава не вярвах, че нещо такова може да ми се случи! Спомням си,че Еми Докузова изпя една народна песен и плакахме заедно с нея. Тогава разбрах, че когато хората са истин ски обединени от една кауза, могат да бъдат голяма сила!
Знам, че сте един от двигатели те на каузата. С какво и как под помагате двойки с репродуктивни проблеми? С нещото, което върша всеки ден – работя. Надявам се и че ще мога да го правя още дълги години, за да свърша моята част от работата,
Вярвам обаче, че когато Висшата сила иска нещо да се случи, тя прави така, че да събере на едно място правилните хора за определе ната
Какво ще направите, ако имате непланирани дни? Ще чета книги, ще отида при дъще ря ми, или ще отида на някое спокой но място в планината. Кой е Вашият личен лечител и как се зареждате? Дъщеря ми е моят лечител. Когато тя е щастлива и всичко с нея е на ред, съм спокойна, мога да работя и да съм полезна на хората. Зареждат ме хубавите книги и добрите хора! Кратка формула на щастието? Да са здрави близките ни хора и ние да сме удовлетворени от това, кое то правим. Да обичаме и да бъдем обичани!
Пожелайте си нещо. Здраве за близките ми и мен и още много родени бебета и щастливи родители!

33 БРОЙ 18 І МЕЧТИТЕ СЕ СБЪДВАТ С ТЪРПЕНИЕ, ВЯРА И ЛЮБОВ
източник на идеи, които претво рява в дела с момичетата на „Ис кам бебе”, и още много други щаст ливи мами. Искам да ви кажа, че ви се възхищавам и много ви обичам! Вие ме карате да искам да бъда мечтател! Разкажете ни за първата Ви среща с „От бебе за бебе” – как се случи и с какво ще я запомните? Първата ни среща беше абсолютна изненада за мен и много вълнуваща.
хора
професиона листи от екипа ни, без които няма ше да имаме тези успехи! Колко е важно да намериш правил ните хора, за да вървиш напред? Смятам, че без правилните хора е просто невъзможно, или ще е твър де изтощително, за да може човек да продължи.
която ще направи още много хора щастливи. Радвам се, че съм част от тези прекрасни
и
мисия.
Медицина Центърът по Майчи но-Фетална Медици на в гр. Пловдив е спе циализирано здравно заведение, което съ четава опита на до казани специалисти и модерна апаратура, за да предостави пър вокачествени грижи на бременните жени.
Управител е д-р Борис Стоилов – акушер-ги неколог и специалист по фетална медицина. Той извършва консул тации и проследяване на бременност, скри нинги за хромозомни и генетични аномалии, фетална морфология, ранна профилактика на усложнения на бремен ността и др. Центъ рът разполага с 3D/4D ехограф от послед но поколение, както и с апаратура за обра ботка на кръвни проби, благодарение на която резултатът от скри нинга в 1-ви тримес тър (т.нар. биохими чен скрининг) е готов в рамките на 2 часа. Сайт: https://pregnancy.bg Телефон за контакти: 0876 222 711

34 І БРОЙ 18 д-р Борис стоилов: „Пренаталният тест не е Панацея, но е доБро Продължение на скрининг в Първи триместър“ БРЕМЕННА СЪМ! какво тряБва да знаем за Пренаталните тестове? разказва д-р Борис стоилов. Д-р Борис Стоилов е акушер-гинеколог и специалист по фетална медицина, завър шил престижния Kings College Hospital в Лондон, Великобритания. Той е управител на Център по Майчино-Фетална Медицина в гр. Пловдив и преподавател в Меди цински Университет – Пловдив. В практиката си извършва консултации и просле дяване на бременност, скрининг за хромозомни и генетични аномалии, фетална мор фология, ранна профилактика на усложнения на бременността и др. Д-р Стоилов е лектор и участник в множество български и международни научни форуми. Ежегодно се включва в националната кампания на радио Витоша „Повече българчета за Бълга рия!“, както и инициира собствени благотворителни каузи. Център по Майчино-Фетална

35 БРОЙ 18 І Телефон за контакти: 0876 222 711 ЦЕНТЪР ПО МАЙЧИНО-ФЕТАЛНА МЕДИЦИНА гр. Пловдив ул. „Знаме“ №4 (в стъклената сграда на медицински център, партер) https://pregnancy.bg
Д-р Стоилов, какво представляват пренаталните тестове? Пренатален скрининг е всяко изследване по вре ме на бременността, кое то не е диагностично, а е насочено към откри ване на определени за болявания или аномалии на плода, включително и ехографското изследва не, скрининг в първи три местър и т.н. Но този израз е приел определе на гражданственост за определен тип изслед вания, а именно високо чувствителен скрининг за най-честите генетич ни заболявания на пло да, чрез установяване на фрагменти от ДНК на плода в майчината кръв –неинвазивен пренатален тест (НИПТ).
Обяснете ни точно процедурата? Болезненa ли е? Има ли риск за бременната? За да се направи НИПТ, е нужно да се вземат някол ко милилитра кръв от ве ната на майката, подобно на рутинните изследва ния, като например за пъл на кръвна картина, кръв на захар и др. Това прави НИПТ напълно безопасен
за майката и плода. Про
бата може да бъде взе та след 9-10 г.с. до края на бременността. Разбира се, важно е какво ще пра вим с резултата, ако го получим непосредстве но преди раждането. От тази гледна точка бре менната трябва да си за даде няколко въпроса:
• Искам ли да знам дали плодът има синдром на Даун или друг синдром?
• Искам да знам на 100% или с голяма вероятност?
• Какво ще правя, ако ре зултатът е позитивен за генетична аномалия? Ще продължа с бременност та на всяка цена, или ще прекъсна при наличие на отклонение?
Какви са индикациите за тестовете? С този тест изследваме най-често за синдром на Даун (тризомия 21), синд ром на Едуардс (тризомия 18) и синдром на Патау (тризомия 13). Пренатал ният тест е изключи телно точен и надежден за изброените синдроми, но въпреки това не е на 100%. Единственият на пълно надежден начин са инвазивните диагно стични процедури – хорионбиопсия и амниоцентеза.

Важно! Правя важно уточнение, за да съм максимално полезен на всички бременни. Тъй като тризомия 18 и 13 са с мно жество аномалии на мозъка, сърцето, крайниците, бъ бреци, коремната стена и др., са лесни за откриване само с ехограф още в 12-13 г.с., но това важи за ехогра фист с достатъчно опит и познания. Тези аномалии са достатъчно тежки и с лоша прогноза, а решението за прекъсване на бременността по медицински показа ния може да се вземе веднага след прегледа от роди телите. По моето мнение тези толкова чувствител ни, но и скъпи тестове, не са нужни за тези амоналии. При тях е редно да се мисли за диагностична процедура, за потвърждение и генетична консултация на двойка та, с цел последващи бременности. Това може да стане с хорионбиопсия/амниоцентеза и абортивен матери ал. В редки случаи може да има неправилно разпределе ние на генетичния материал (балансирана транслока ция на хромозомите) при единия родител и това да е причина за поредица от аборти и несполуки, за което съветваме да се направи генетична преконцептуална консултация.
По друг начин стоят не щата за тризомия 21 или синдром на Даун. Този синдром може да има мно жество ехографски и био химични отклонения, които да ни наведат на мисълта за него, още при скрининг в първи тримес тър, който се прави от специалист по фетал на медицина в 11-13 г.с. Но може да има едва забeле жими и дискретни проя ви, или да се изяви на късен етап от бременност та, така че откриването му да е доста по-трудно, дори за опитен специа
36 І БРОЙ 18
БРЕМЕННА СЪМ!
лист. В практиката си следвам само утвърде ни медицински препоръки, според които след скри нинг в първи триместър, който показва висок риск от синдром на Даун, един от вариантите е да се на прави неинвазивен прена тален тест. На този етап пренаталният тест все още е относително скъп. Цената започва от 700 лв. за базовия пакет, кой то обхваща синдром на Даун, синдром на Едуардс, синдром на Патау, поло вите анеуплоидии и пола на плода.

Колко са надеждни? Тук ще отворя две скоби
– едната за чести грешки при използването на НИПТ и за обхвата му. Много чес то неинвазивният прена тален тест се смята за панацея! Тестът е изклю чително добър за синдром на Даун! Факт! По-горе оп исах за синдром на Едуардс и Патау и че според мен не е нужен за тях. Тази го дина излязоха резултати те от мащабно проучване за синдром на Ди Джордж, което показва че с НИПТ може да идентифицираме и него с голяма увереност (виж статия*). Имам много компании, кои то предлагат тестът да се използва за още мно го генетични заболявания. Дали може да ги открие?
Да, но с каква точност и колко от бебетата със съответното заболява не ще изпусне, е игра на ези-тура.
Каква е разликата между скрининг в 1-ви триместър и пренатален тест?
Много от ентусиазира ните и развълнувани ро дители бързат да напра вят НИПТ преди скрининг в първи триместър по различни причини. Някои дори решават да не пра вят прегледа в 11-13 г.с., тъй като „това е само статистика“. Да, статис тика е! Но този преглед ни дава много голямо количе ство и много ценна инфор мация за цялата бремен ност, която на следващ етап няма как да се полу чи. А още по-важното е, че след скрининг в пър ви триместър може да се предприемат действия, които да подобрят и по могнат за добрия изход от бременността. Важно е да отбележа, че още в 12 г.с. с това изследване могат да се открият тежки анома лии на плода, които са не съвместими с живота или водят до тежка инвалиди зация, но да не са генетич ни. Тоест няма как да бъ дат открити от НИПТ, но
37 БРОЙ 18 І КАКВО ТРЯБВА ДА ЗНАЕМ ЗА ПРЕНАТАЛНИТЕ ТЕСТОВЕ?
могат да се открият при ехография. Надявам се сега да е ста нало по-ясно какъв да е ре дът: • 1-во се прави скрининг в първи триместър. • 2-ро, при желание, се из вършва НИПТ.

БРЕМЕННА СЪМ! 38 І БРОЙ 18
Редно е да си поговорим и за причините да напра вим НИПТ. Много от ро дителите избират да го направят за тяхно спо койствие. Това несъмне но е добър избор, защото на практика изключваме най-честите анеуплои дии (тризомия 21, 18 и 13). Друга честа причина, за да изберем да го напра вим, е висок риск за някое от тези заболявания при скрининг. По-рядко и мал ко спорно според мен е из бор на НИПТ при откри ти ултразвукови маркери за генетични дефекти. Аз съм по-скоро да се напра ви генетично изследване с хорионбиопсия/амниоцен теза, за да знаем на 100% и с по-разширено изслед ване на гените. За по-лю бопитните – можете да прочетете някои от ста тиите ни в сайта на Цен търа по Майчино-Фе тална Медицина www. pregnancy.bg. Препоръчвате ли пренаталния тест при бременни с донорска яйцеклетка? Бременните след IVF про цедури са особено чувст вителни и би било чудесно, ако могат да си го позво лят финансово, за да са по-спокойни поне в пе
риода на бременността. Бъдещите майки с донор ски материал също могат да се възползват от това изследване. При бременни с близнаци препоръчва ли се пренаталният тест? Отчитат ли се резултати и за двете бебета? Пренатален тест може да се направи както на бре менна с едноплодна бре менност, така на бре менна с два плода, но не с повече. Един тест е дос татъчно чувствителен, за да определи зиготност та, но при наличие на гене тичен дефект последва щата инвазивна процедура ще бъде на двата плода, за да идентифицира точно кой е засегнат. В ранните срокове може да се спре сърдечната дейност на за сегнатия плод (при опре делени условия) и бремен ността да продължи като едноплодна само на здра вия плод, при желание от страна на родителите. Ако резултатът от пренаталния тест отчита проблем, как се реагира?

При получаване на положи телен резултат от тес та е редно да се потвърди чрез инвазивна процеду ра – хорионбиопсия или ам ниоцентеза. Длъжен съм да информирам, че всяко пре късване на бременността след 12 г.с. без медицински индикации е криминално деяние.
Внимание! Положителен резул тат от НИПТ НЕ Е дос татъчна причина за прекъсване на бремен ността, защото това е скрининг, но не и диа гноза. Амниоцентеза може да се наложи и на по-късен етап от бременността пора ди съмнение за други гене тични дефекти, фетал ни инфекции и структурни аномалии на плода. Много от пациентите не са за познати с рисковете при амниоцентеза и погрешно я приемат за твърде ри скова – рискът за аборт
да продължат или прис тъпят към прекъсване на бременността. Надявам се с тази крат ка статия да внеса малко повече яснота по темата за неинвазивните прена тални тестове. Въпреки всички неизвестни и поли тически борби, в мен все още има надежда, че на оп ределен етап държавата ще приоритизира бремен ните жени и бъдещето на България, в лицето на ро дените и неродените им деца, и ще регламентира дейността на пренатал ната медицина, както и ще субсидира всички необхо дими изследвания.
Пожелание На всички бременни ис кам да пожелая спокой на, лека и безпроблем на бременност и здрави деца, които да ги рад ват. Благодарение на напредъка на медици ната много от здра вословните проблеми могат да бъдат разре шени, така че бремен ността да завърши ус пешно.
*Статия: Cell-free DNA screening for prenatal detection of 22q11.2 deletion syndrome: https://doi.org/10.1016/j. ajog.2022.01.002
след
ки
на оконча телния резултат от хори онбиопсия/амниоцентеза се прави генетична консул тация и ако има тежък ге нетичен синдром,
телите преценяват дали
тази процедура е 1 на 1000 процедури. Нека все
сам прецени какво озна чават за него тези цифри. След получаване
роди
ЗА
ТЕСТОВЕ? 39 БРОЙ 18 І
КАКВО ТРЯБВА ДА ЗНАЕМ
ПРЕНАТАЛНИТЕ
Представяме ви д-р Нели Манолова-Таскониду. Тя е родена в гр. София на 02.10.1984 г., омъжена, с две деца. През 2007 г. успешно завършва „Молекулярна биология“ към Биологиче ския факултет на Софийския университет „Св. Климент Охридски“, а през 2009 г. придобива образователно-квали фикационна степен магистър със специалност „Вирусоло гия“ към същия университет. От 2008 до 2011 г. работи в Националната референтна лаборатория за ГМО към На ционалния Център по обществено здраве
клиничен ембриолог Мар тина Вьобер – един от най-добрите ембриолози в Ав стрия. Така, работейки 5 години в един от най-успеш ните инвитро центрове в София, в ежедневната си практика успява да се докаже като специалист с широ ка теоретична и практична подготовка. От 2016 г. е на значена като главен ембриолог в инвитро центъра на проф. Щромер в „Токуда Болница“ София. В периода 2017-2020 г. успешно ръководи инвитро и андрологичния сектор на Отделението по асистирана репродукция към УМБАЛ „Лозенец“. От 2021 г.
на

40 І БРОЙ 18 Д-Р НЕЛИ МАНОЛОВА-ТАСКОНИДУ: „ИСКАМЕ ДА ВИДИМ ЩАСТИЕТО И ЛЮБОВТА В ОЧИТЕ НА ПАЦИЕНТИТЕ СИ“ В КАДЪР: ЕМБРИОЛОГЪТ
В периода от
продължава
Българска
на науките
и имунология на размножаването (ИБИР), където успеш но защитава докторска дисертация в областта на Ре продуктивната имунология на тема „Биохимична харак теристика на ендометриозна перитонеална течност“. Професионалният й опит в областта на асистирана та репродукция започва в началото на 2012 г. като ем бриолог в екипа на „Виена Ин Витро Медицински Цен тър“ под ръководството на проф. Хайнц Щромер. Преминава продължително обучение в областта на ем бриобиотехнологиите и асистираната репродукция в „Kinderwunschzentrum Goldenes Kreuz“, Виена, Австрия под ръководството
става част от екипа на Медицински Център „НЕОВИТРО“ и през 2022 г. отново поема ръководство то на Инвитро и Андрологичния сектор в клиниката. Посещава активно международните конгреси на Евро пейската асоциация по човешка репродукция и ембрио логия и годишните срещи на Българската асоциация по стерилитет и репродуктивно здраве. Член е на Европейската асоциация по човешка репродук ция и ембриология (ESHRE). В свободното си време оби ча да пътува и да бъде сред природата със семейство то си и приятелите.
и анализи.
2010 до 2013 г.
обучението си в
академия
в Института по биология
старши
Д-р Манолова, какво се крие зад тази професия –ембриолог? С какво точно се занимавате вие, ембриолозите? Какво се случва в онзи момент, в който яй цеклетката е извън тялото на жената и тепърва започва да се разкриват тайните й? Ембриологията е една изключително всеобхватна, вълнуваща и в същото време сложна наука. Това е една от най-бързоразвиващите се области в медицината, в която учените всеки ден се опитват да разгадаят начини те и принципите на всички етапи и процеси в това най-ранно развитие на един човешки организъм. Ще се постарая, с няколоко думи, да обри сувам основните дейности на един ембриолог: работата на ембриолога започва след аспирирането на фоли кулната течност по време на пунк цията. Прецизно, под микроскоп, той започва търсенето на яйцеклетки. След откриването им, овоцитите внимателно се прехвърлят в специ ални петрита, съдържащи хранител ни среди, предоставящи оптимални условия за култивиране извън орга низма на жената. Тези петрита през цялото време се намират в инкуба тори, които поддържат постоян на температура, определен газов състав и влажност. Колегите от Андрологичния сектор имат важна та задача да обработят и пречис тят семенната проба, с която ще бъде направено оплождането. След като тя бъде готова, се премина ва и към този процес. Оплождането може да бъде извършено основно по два начина: по класически път (чрез
класическо инвитро оплождане) или чрез инжектиране на един спермато зоид вътре в цитоплазмата на яй цеклетката (по-известно като ICSI оплождане). Тук е мястото да вмет на, че в нашата клиника максимал но се стремим да се доближаваме до по-естествените, по-щадящи и не инвазивни техники. Ако семенната проба е с подходящи параметри (кон центрация, подвижност и морфоло гия) и с помощта на допълнителни изследвания и тестове, ние в пове чето случаи предпочитаме да прило жим класическо инвитро оплождане. Разбира се, когато има налице инди кации, че това не може да се случи и че семенната проба не е с добри па раметри – се предприема директно то инжектиране на сперматозоид в яйцеклетката. От съществено зна чение за нас е пациентите да бъдат информирани за вида на оплождане то и точния брой яйцеклетки, кои то ще бъдат оплодени по единия или другия начин. Ние съветваме и изказ ваме мнение като специалисти кой вариант би бил по-подходящ в даде
ния случай, какви са плюсовете и ми нусите, но винаги последната дума остава на пациента! За нас това е из ключително важно – да успеем да из градим спокойствие, хармония и до верие помежду ни! Детайлна оценка Следващите няколко дни, след оп лождането, преминават
развитие. И от ново – ежедневно информираме пациентите по телефона за раз витието на ембрионите им. На 5-и ден от култивирането ембри ологът трябва да прецени добре и да подбере този ембрион / и, който има висок имплантационен потенциал, и да го трансферира, заедно с помощта на лекаря и аку шерката, в маточната кухина на жената. А ако има още качестве ни ембриони – трябва да ги замра зи за евентуални следващи опити.

41 БРОЙ 18 І
Д-Р НЕЛИ МАНОЛОВА-ТАСКОНИДУ
в култи вирането и образно казано в „гри жите“ за най-малките създания. Всеки ден се прави детайлна оцен ка на тяхното
Накратко, това представлява рабо тата на един ембриолог, като, раз бира се, има още много процедури, за които тук нямаме достатъчно въз можност да опишем по-подробно. Ако се върнете години назад, бихте ли заменили професията на ембриолог с друга? Как се „запалихте“ за тази работа? Още от ученическите си години, а и след това като студент, моето ос новно желание бе да помагам на хо рата, прилагайки знанията и умени ята, които имам. Така, с годините, натрупвайки много практически опит, се насочих към професията
ембриолог. Този мой избор бе и като един естествен завършек на док торската ми дисертация, а имен но в областта на репродуктивната имунология. Колкото и отговорна да е тази професия, не бих я заменила с друга, защото няма нищо по-хубаво и удовлетворяващо от това да зна еш, че с твоя труд, усилия и знания си сбъднал най-съкровеното желание на една двойка – да се сдобият с дете. Към днешна дата – какво е за Вас безплодието? И къде можем да търсим отговора на въпроса: кои са причините за безплодието? Безплодието основно може да се

42 І БРОЙ 18
В КАДЪР: ЕМБРИОЛОГЪТ
раздели на две групи: едната група се свързва с проблеми от страна на мъжа (мъжки фактор), а другата –проблеми от страна на жената (жен ски фактор). През последните години все по-често се наблюдават откло нения в първата група. Пандемията от коронавирус сякаш допълнително засили тези отклонения, които се на блюдават при анализа на една семен на проба. За щастие те са временни и обратими, за разлика от генетич ните процеси, които настъпват с напредване на възрастта при же ната. Наблюдава се все по-късно то планиране на бременност, което за съжаление се превръща в тенден ция. Биологичните процеси на ста
реенето оказват силно негативно влияние както върху качеството на яйцеклетките, така и върху морфо логията и имплантационния потен циал на самите ембриони. Би било добре известната фраза „40 са нови те 20“ да се среща по-рядко – затова, ние, репродуктивните специалисти, силно апелираме!
Какво се промени в раз бирането и лечението на безплодието през годините от гледна точка на ембриологията? Ембриологията е бързоразвиваща се

наука, която всеки ден ни предлага по нещо ново. Внедряват се все по вече иновативни методики, които биха могли да се приложат в лечение то на стерилитета при двойката, като, разбира се, се подходи и стро го индивидуално. Все по-широк об хват в нашата ежедневна дейност намират донорските програми как то с донорски сперматозоиди, така също и с донорски овоцити. Предра

съдъците относно „чуждия“ генети чен материал сякаш остават на за ден план. Все по-често се наблюдава и повишаване на интереса към опаз ването на репродуктивния капаци тет (криоконсервация на собствени яйцеклетки и сперматозоиди). Хуба вото е, че пациентите са отворени към новостите, които се предлагат, и дори самите те търсят онези кли ники, които биха могли да им ги пред ложат.
Къде един ембриолог търси причината в поредицата от неуспешни опи ти инвитро? Различните неща, които правите в „НЕОВИТРО“? Изключително важно е да се подхо ди индивидуално към казуса на двой ката. Да се разгледат в детайли пре дходните неуспешни процедури, да се вземе решение какво би могло да се подобри или промени при насто ящата ситуация. Затова успешното разрешаване и завършване на случая
43 БРОЙ 18 І
Д-Р НЕЛИ МАНОЛОВА-ТАСКОНИДУ
се осъществява единствено с добра та екипна работа и пълната инфор мираност на пациентите за всяка една стъпка от тяхната процеду ра! Това е едно от основните неща, които ни отличават от другите. Всеки един от екипа посещава раз лични обучения и конференции, като непрестанно се стремим да внедря ваме в нашата ежедневна практика най-съвременните тенденции, кои то се прилагат по света – второ поколение PRP на ендометриум и яй чници; неинвазивна PGD диагности ка на ембрионите; прилагане на раз нообразни тестове и методики за подобряване на мъжкия стерили тет (тестове за определяне на фи зиологичната функция и оплодител на способност на сперматозоидите; определяне на оксидативен стрес; селектиране на сперматозоиди с ви сок оплодителен потенциал непо средствено преди извършване на оп лождането и др). Тук е и мястото да благодаря на нашия ръководен екип, който изцяло ни подкрепя и е отво рен към иновациите, защото имаме една-единствена обща цел – да ви дим щастието и любовта в очите на
пациентите си!
Кога, според Вас, възниква животът? Откривате ли връзка между науката и чудото на живота? Работейки тази благословена про фесия, имам честта и привилегията да виждам със собствените си очи възникването на новия живот. Ако трябва да отговоря като учен, жи вотът възниква при сливането на двете полови клетки – яйцеклетка та и сперматозоида, и това трябва да е един естествен и нормален про цес спрямо основните функции, кои то изпълняват тези два вида клет ки. Но ако трябва да отговоря като един обикновен човек – бих казала, че това е едно истинско чудо! Все ки ден, когато отивам на работа и застана пред микроскопа, с притаен дъх и вълнение очаквам да видя „чу дото“ – че яйцеклетките са се оп лодили нормално; доброто развитие на малките ембриончета и, разбира се, кулминацията – да видя позитив ния тест за бременност на пациент ката и щастието в очите й! Така че, бих отговорила, че науката и „чудо то на живота“ вървят ръка за ръка и са преплетени в едно – само силната вяра, че то ще се случи, го прави ре алност!
Имали ли сте случаи, при които сте направили всичко възможно, но не се е получил добър ембрион (според критериите на ембриологията), но жената е забременяла? Както и обратно – получават се добри ембриони, а не се случ

44 І БРОЙ 18
В КАДЪР: ЕМБРИОЛОГЪТ
ва желаната бременност?
Как си обяснявате тези неща? Разбира се, в практиката си съм има ла и такива случаи. Тогава е трудно да се обясни резултатът. Възмож но е ембрион с по-лошо качество ус пешно да се развие и имплантира. Това би могло да се дължи на отлич ната рецептивност на ендометри ума в този момент, както и на до пълнителните техники, които сме приложили, за да подпомогнем ус пешното му развитие. От голяма важност е и психоемоционалното състояние и способността за регу лиране нивото на стреса при паци ентката както по време на самата процедура, така и след нея. Но не трябва да забравяме и частицата божествена сила, която дава нача лото на новия живот! Откъде черпите най-много сили и вдъхновение, за да продължавате да работите в сферата на асис-
тираната репродукция? Както споменах и по-напред, най-го ляма удовлетвореност и най-много сили ми дават радостта и щастие то на двойката пациенти, прегърна ли своето детенце. В този момент разбираш, че всичко, което си напра вил, си е струвало, а умората и при тенененията избледняват! Няма нищо по-хубаво от това да видиш, че трудът и силите, които си вло жил при този нелек и труден път, който заедно сте извървели, е завър шил с успех. Кои са най-големите Ви страхове – в медицината и в живота?

Опитвам се да приемам нещата та кива, каквито са – било то добри или лоши. Разбира се, и аз като родител се притеснявам дали отделям дос татъчно внимание и грижи за свои те деца; дали успявам да им дам до бро възпитание и любов! Страхувам се, като всеки нормален човек, от за губа на най-близките ми хора. От про
фесионална гледна точка за мен липса та на желание, мотивация и развитие са най-вредните неща, които биха се проявили у един специалист, защото неминуемо това ще доведе до небла гоприятен изход от процедурата. Кой е Вашият личен лечител? Моят лечител са приятното време, прекарано сред природата, колеги те, приятелите и семейството ми. Те ме зареждат истински и ми дават нови сили.
Вашите думи към семей ствата, които все още са в очакване на рожба? Бих искала да посъветвам семей ствата/двойките, които са в очак ване на дете, да не се страхуват да предприемат крачката към репро дуктивния специалист, да разберат, че няма нищо срамно или грешно; да не отлагат за дълъг период във вре мето бременността – особено ва жно послание, което бих искала да достигне до повече жени, тъй като с времето настъпват необратими процеси както на генетично, така и на физиологично ниво. За двойките, които вече са пациен ти, бих искала да им пожелая да не гу бят вяра и надежда, че чудото ще се случи. Разбира се, не трябва и да се „пренавиват“, защото тогава разо чарованието ще е още по-голямо и стресът, който би изпитала жена та, може да я доведе до емоционален срив. Затова е хубаво да се намери златната среда – умерено да вярва ме, че заедно, с общи усилия, ще из вървим пътя към желаната мечта! Успех!
45 БРОЙ 18 І
Д-Р НЕЛИ МАНОЛОВА-ТАСКОНИДУ
25-годишна преподавателска практика в Катедра „Анатомия, хистология и ембриология“ на МУ-Пловдив и има същата специалност. Родом е от Велинград, завършва медицина в МУ-Пловдив през 1989 г. Съучредител и постоянен медицински консултант на пациентската организация Сдружение „Зачатие“, обединяваща хора с репродуктивни проблеми в България. Работи в собствен Център по репродуктивно здраве в Пловдив. Можете да намерите повече информация на http://www.invitro-plovdiv.com/.

46 І БРОЙ 18 НАШИТЕ ДОКТОРИ Д-р Даскалова, спомняте ли си кой Ви насочи към лекарската професия и защо я избрахте? Да си лекар не е професия, а начин на мислене и със тояние на духа. Спомням си, че на 18-годишна възраст имах дилема – да продължа в професионалния спорт, където за да си успешен, трябва да победиш против ника, или да правя точно обратното и да помагам на хората. Избрах да помагам. В онези години не беше лесно да следваш мечтите си и да избереш това, в което ще си най-добър. Затова се радвам, че намерих своя път. „ПРОФИЛАКТИЧНАТА МЕДИЦИНА ЩЕ СПАСИ СВЕТА“ Д-р Мариела Даскалова е лекар с
Кога и коя беше причината да се насочите имен но към репродуктивната медицина? Това вече стана съвсем случайно. В началото на достъпа ми до интернет, а това беше в края на 2000 г., попаднах в един чат, в който няколко души ко ментираха дозите на ле карствата за овариална стимулация и си разменяха линкове към чуждестран ни статии за асистира на репродукция. В първия момент реших, че съм се присъединила, без да ис кам, към група колеги, кои то това работят. Стана ми интересно и се вклю чих в дискусията. Чак то гава разбрах, че това са всъщност пациенти, кои то търсят информация и си обменят знанията, за да си помогнат взаимно. Бях удивена от тяхното жела
ние да са полезни за други те, от решимостта им да се справят, от техните познания, макар да нямаха медицинско образование. И така започна всичко...
Ще Ви върнем години на зад, във времето, когато за безплодието се говореше тихо и със срам. Или въобще не се говореше. Именно в такова време се ражда Сдружение „Зачатие“, на което Вие сте сърцето. Разкажете ни за това Начало, за труд ностите и радостите на „Зачатие“ и Вашата роля като лекар в това начинание. В началото беше наисти на много, много трудно. Нямахме нищо – пари, дос тъп до медии, механизми за повлияване на държава та, имахме само ентусиа зъм. Всички ние, основате
лите на „Зачатие“, имахме друга работа, от която се издържахме, и в сдруже нието влагахме личното си свободно време. Веднага срещнахме отпор, негати визъм, безразличие, а има ше и хора, които активно се опитваха да ни пречат. Плакала съм от безсилие и отчаяние, че нищо не мо жем да постигнем и няма ме подкрепа отникъде. И когато за първи път една телевизия откликна на же ланието ни да говорим пуб лично за безплодието, беше огромен пробив. Спомням си вълнението, с което се подготвихме за предава нето, като участие взеха и пациенти – мъж и жена, които разказаха за свои те здравословни пробле ми лично, без да се притес няват да покажат лицата си и без страх, че ще бъдат осмивани.
Промени През годините не мога да кажа, че стана по-ле ко, защото зад всяка ини циатива, която изглеж да добре организирана и преминава плавно, сто ят часове работа на от дадените на каузата до броволци. А ние успяхме да организираме и прове дем десетки събития, с подкрепата на медицин ски специалисти от цяла та страна осигурихме ин формация и подкрепа на стотици двойки с репро дуктивни проблеми. Осо бено нескромно се гордея с уникалната инициати ва „Ден на репродуктив ното здраве“, която еже годно събираше на едно място пациенти и спе циалисти в течение на почти 15 години. Проме ниха се много неща – ос новно обществените на гласи, заедно с фондация „Искам бебе“ се пребо рихме за държавно и об щинско финансиране, цен тровете по асистирана репродукция се увеличи ха, промени се и законода телството, така че хо рата с безплодие да имат достъп до повече защи ти, ресурси и специа листи и това да става значително по-лесно, от колкото преди години.

47 БРОЙ 18 І „ПРОФИЛАКТИЧНАТА МЕДИЦИНА ЩЕ СПАСИ СВЕТА“
Като лекар 20 години про веждах безплатни консул тации на пациенти от ця лата страна, с желанието да им помогна да се ори ентират по-бързо, да се
справят по-лесно, да не
на безплодието. Дадох едно рамо и на държавата да адаптира законодател ството спрямо съвре
менните постижения на репродуктивната медици на. Изобщо, опитвах се да стоя на страната на па циентите и да защитавам техните права, колкото
48 І БРОЙ 18
им е
по пътя
самотно
НАШИТЕ ДОКТОРИ
и негативи да ми е носило това в условията на наша та държава. Най-честите причини за безплодието, според Ва
шата практика – медицински, социални, психо логически? Безплодието е медицински проблем. Здравните при чините за безплодие са де сетки. За жалост, от ме дицински проблем често се превръща в социален и психологически, заради сложния път на диагно стиката и лечението и по ради факта, че да искаш да имаш дете и да не можеш е травма както за двойка та, така и за всеки парт ньор поотделно. Често в тази нелека житейска си туация се замесват родни ните, приятелите, колеги те, съседите и т.н. В някои случаи обратно, двойката не желае да сподели с нико го заради съществуваща та стигма и дискримина ция и това прави живота им още по-труден. Отдел но, но не маловажно, някои медии съдействат в раз пространението и рекла мата на неправилни здрав ни практики и подходи към безплодието и това е до пълнителна тежест върху тези хора. Вие сте един от най-до брите специалисти в областта на мъжкия стери литет. Какво се промени, като глобална визия, в го дините по отношение на диагностиката и лечението на този проблем,
ако сравним 2005-а с 2022ра година? Първо, научихме мъжете да правят спермограми. Не можем да се преборим с не законните практики да се правят спермограми в не лицензирани лечебни за ведения, но поне има дос татъчно такива, в които мъжът може да получи на истина добро, качествено лабораторно изследване. Второ, научихме мъжете да ходят на лекар. Защо то обикновено здравите, млади хора не се досещат да се обърнат към спе циалист, ако нямат никак ви оплаквания – а това е коварството на безпло дието. Трето, вече имаме достъп до различни диагностич ни инструменти, които могат да установят как ва е причината при мъжа да има репродуктивни за труднения. Все още няма ме достатъчно обучени андролози, но се надявам и това да се случи в следва щите години. Изобщо, нещата вървят в правилната посока, но малко бавно за моето раз биране за живота. Откъде да започнем, ако бебето се бави? Обик новено жената е тази, която тръгва по лекари. Какво обаче трябва да направи мъжът в двой
ката? Мъжът трябва да отиде на лекар. Колкото е прос то, толкова е и сложно. В едно бъдещо по-добро здравеопазване ще има яс нота към кого да се обър не мъжът в инфертилна та двойка за първоначална консултация и оценка на репродуктивното здраве и неговият път ще е ясен и значително по-къс. До пълнителна трудност за мъжете е концентраци ята на специалисти само в няколко големи града на страната, като и множе ството недостоверна, фалшива и понякога вред на информация в интер нет.
Нека да обърнем вниманието си към биологич ния часовник на жената и на мъжа. Коя е най-до брата възраст за раждане на първо дете и какво ни коства социалното изместване на тази въз раст? Няма как да избягаме от отлагането на родител ството, то идва с циви лизацията и желанието за по-добро образование и социален статус. Също и с разкъсаните връзки меж ду отделните поколения, които сега не си помагат достатъчно, както е било преди години – няколко по коления са споделяли една
49 БРОЙ 18 І
„ПРОФИЛАКТИЧНАТА МЕДИЦИНА ЩЕ СПАСИ СВЕТА“
къща, бит и ценности. Статистика Все пак у нас отлагане то на майчинството не е толкова драматично, кол кото е другаде по света. Ако се сравним с европей ските държави за петго дишен период от вре ме, ние сме в дъното на таблицата. Средно за Ев ропа възрастта на май ката при раждане на пър во дете е била 28.7 г. през 2013 г. и 29.1 г. през 2017 г., като в няколко държави е над 30-годишна възраст. За България тези стой ности са съответно 25.7 г. и 26.1 г. Тук, разбира се, трябва да отчетем и ражданията в много мла да възраст, което е от делен проблем. Извън полезрението на об ществения интерес ос тава възрастта на мъжа. Нямаме статистически данни на колко години мъ жете в България стават бащи за първи път, но да нните от други държави показват, че отлагането на бащинството е в сила с течение на годините, като причините вероят но са еднакви и при двата пола. На медицинската на ука е известно, че бащин ството след 50-годишна възраст също крие свои те рискове. И докато при
жените намаляването на фертилността с възрас тта е добре документи рано, то при мъжете този факт е недостатъчно проучен в детайли.

Според Вашия опит, кои са рисковите фактори за безплодие при мъжете? Аз съм яростен противник на цигарите и агитирам всички мъже, които се об ръщат към мен за помощ, да спрат да пушат. Докол ко успявам е друг въпрос. Липсата на движение и за седналият начин на жи вот, неправилното хране не и наднорменото тегло,
употребата на анаболи и наркотици, напредналата възраст и сексуално-тран смисивните заболява ния са част от рисковите фактори при мъжете. Но най-вече, и това е така от години, забавя нето, отлагането на ди агнозата, страхът и не желанието да се потърси професионална помощ и хронифицирането на забо ляванията.
Кога да посетим специа лист по мъжки стери литет? Кои са първите „червени лампички“, които ни показват, че е въз-
можно да има проблем със зачеването именно при мъжа? Веднага, бих казала, след като решат да имат деца. Профилактичната ме дицина е тази, която ще спаси света. Няма поч ти нищо, което да под сказва, че един мъж може да има репродуктивни за труднения. Затова и чес то мъжете казват, че са изненадани от лошите си резултати, като изобщо не са подозирали за нали чието на някакъв проблем. Затова – профилактика. Колко е важна, според Вас,
50 І БРОЙ 18
НАШИТЕ ДОКТОРИ
екипната работа в ре продуктивната медицина? Изключително важна! Вре мето на енциклопедисти те е отминало отдав на. Никой не може да знае всичко, а репродуктивно то здраве е такава област от медицината, в която имаме нужда от много на брой специалисти с раз лични области на позна ние. Трябва да отбележа, че екипната работа е не долюбвана и понякога ле карите работят сами, оп итвайки се да покрият всички възможни проблеми и техните решения. Това води до субоптимална ди агностика и лечение. От друга страна, и пациенти те очакват един лекар да реши всичките им пробле ми и понякога изразяват недоволство от препра

щането на различни спе циалисти. Но така е пра вилно – всеки специалист да знае своите възмож ности и ограничения и да обясни на пациента докъ де може да помогне сам и къде се налага да потърси помощ от друг колега.
Защо е толкова важен индивидуалният подход при лечение на безплодието? Защото всеки човек е една Вселена. Всеки е индивиду алност, ако подходим „на конвейер“, вероятно също ще постигнем някакъв ус пех, но няма да можем да помогнем точно на тази група хора, които най-мно го ще се нуждаят от по мощ. Вярно, ако влезем в коловоза, ще ни е лесно. Но в медицината не е важно да ти е лесно, а да си ефек тивен.
Кои са по-смели, когато има репродуктивен про блем в двойката – жени те или мъжете? Най-смели са двойките. Осъзнаването, че пробе мът не е индивидуален, носи сила и огромни въз можности за справяне, по-малко страдание и побърз прогрес. Какво казвате на семей ствата, когато се получи отрицателният тест за бременност, за да пре одолеят последващата криза? Няма универсален отго вор, няма рецепта за сп равяне. Всеки преодоля ва житейските несгоди по собствен, индивидуа лен начин. Доколко лека рят е този, който може да им помогне, е въпрос на предварително изгра дени взаимоотношения между пациента и лечи теля. В такива ситуации обикновено любовта ми към хората ми помага да подбера правилната ре акция – може да е само дума, поглед или подадена салфетка, друг път е план за действие, понякога е тирада, а понякога съм просто безсилна и не мога да се справя. Но едно нещо не забравям да им кажа – че медицина та напредва и за много не решими в миналото про
блеми сега имаме изход. Единствено непоправимо е, ако спрат да се обичат.
Откъде черпите най-много сили и вдъхно вение, за да продължава те работата с хората с репродуктивни про блеми?
От самите хора. От тях ната обратна връзка. Лю бовта и благодарността, която получавам години на ред. Критиката и омраза та, когато не съм успяла да им помогна. Всяка еже дневна емоция, сълзите на радост или мъка, цве тето и лошата дума, бук вално всичко се опитвам да превърна в съзидател на енергия. Е, вроденият ми инат и чувството ми за ху мор също помагат. Да бъ деш застъпник за правата на пациентите е самотна, ветровита позиция, която привлича критиките от най-различни посоки. И чес то точно оттам, откъде то най-малко очакваш.
В такъв случай, кои са най-големите Ви страхо ве в медицината и в жи вота? Агресивното невежество. И в медицината, и в жи вота.
А кой е Вашият личен лечител? Чистата съвест.
51 БРОЙ 18 І „ПРОФИЛАКТИЧНАТА МЕДИЦИНА ЩЕ СПАСИ СВЕТА“

НАШИТЕ ДАРИТЕЛИ ОДА ЗА ДОБРОТО Понякога един малък жест на съпричастност може да ни направи големи! В тази простичка истина се убедих ме преди време, когато срещнахме очите на едно малко момиче с огромно сърце! До нас, в ИСКАМ БЕБЕ, дос тигна новината, че малката Ема Константинос Колокасидис е пожелала да дари паричките от касичката си, за да се роди бебе. Как да не вярваме после в Доброто? Ние, хората от ИСКАМ БЕБЕ, които ежедневно се сблъскваме със съдбите на хората, мечтаещи за дете, сме свидетели на постоянно случващото преобръщане на нещата – от мъка към радост и от безнадежност –към Чудо! Когато помолихме Ема да се представи, тя започна така: „Казвам се Ема, на 9 години и половина, уча в 120-о Основно училище „Г. С. Раковски“ в София, с директор г-жа Цветанка Тонева“. 52 І БРОЙ 18
КАКВО Е ТВОЕТО ХОБИ, ЕМА?
Обичам да си рисувам, да си попъл вам Дневника и да гледам някакви неща, които ме учат на Добро! ДОБРО ЛИ? КАКВО ОЗНАЧАВА ЗА ТЕБ ДОБРОТО?
Добро е например да казвам „Бла годаря“, да помагам на хората, да уважавам другите хора и… мама. КАЖИ НИ КАКВО ДОБРО СИ ПРАВИЛА?
Ние с мама обичаме да помагаме на хората. Един път, бяха ми останали парички – ресто от сладоледа. И вместо да ги дам на мама, реших да ги дам на едно момче, което свиреше на гъдулка в центъра на Ботевград.
КАКВА ИСКАШ ДА СТАНЕШ, КО ГАТО ПОРАСНЕШ ГОЛЯМА? Искам да стана учителка. Преди исках да стана пожарникарка, но най-важното е да стана човек, който помага на хората.

РАЗБРАХМЕ , ЧЕ ТИ САМА СИ РЕШИЛА ДА НАПРАВИШ ДАРЕ НИЕ С ПАРИЧКИТЕ ОТ ТВО ЯТА КАСИЧКА. КАК СЪБИРАШ ПАРИЧКИ ТАМ?
на и аз. КАКВО ИСКАШ ДА ИМ ПОЖЕ ЛАЕШ НА ТЕЗИ ХОРА? Искам да им пожелая късмет и да са много щастливи. И да имат бебе! КАКВО ИСКАШ ДА КАЖЕШ НА ВСИЧКИ ХОРА ПО СВЕТА? Да са живи и здрави и да правят само добро. Защото ако направят нещо лошо – то ще им се върне! Например, ако имаш един лев и някой беден чо век ти го иска, трябва да му го да деш. Така се случва с доброто. Пра виш го и ти се връща добро. А КАКВО ИСКАШ ДА КАЖЕШ НА ТВОИТЕ СЪУЧЕНИЦИ И ПРИЯ ТЕЛИ? Искам да са добри, да не се бият. Ако са тъжни – да не дават тъга на другите хора, а да си прегърнат ку ченцето и така тъгата ще си отиде. А КАКВО ИСКАШ ДА КАЖЕШ НА МАМА? Да е все така добра и да ме учи да по магам. ПОЖЕЛАЙ НЕЩО НА ЧИТАТЕЛИ
ОДА ЗА ДОБРОТО
Събирам парички от закуските, или ако ми останат, когато мама ми е дала повече. Така реших да дам спес тените парички на една жена, която няма бебе. Те са направили 15 проце дури, за да имат бебе, но все не ста ва. И така реших – искам да помог ТЕ НА СПИСАНИЕТО НИ. Да са живи и здрави и да не се отчай ват никога! ЗА СЕБЕ СИ КАКВО ИСКАШ? Искам да живея дълго и да продължа вам да правя добри неща. 53 БРОЙ 18 І
НОВИНИ В БЯЛО
Има срещи, които не се забравят!

ЯНИ
И ВЕСИ
Преди години в ИСКАМ БЕБЕ се за познахме с Веселина Добрева – сту дентка по медицина, която особено ни вдъхнови с хъса си да бъде лекар и, разбира се, с огромното си сърце! В годините направихме много срещи и събития в подкрепа на каузата – да се раждат деца в България и младите хора да остават тук, защото имаме нужда от лекари като Веси и нейни те прекрасни колеги! Веселина и нейният партньор Яни сключиха брак през септември. Щастливото семейство ЧОБАНОВИ събраха на сватбата си 880 лева и ги дариха на ИСКАМ БЕБЕ!
от 265 лева и я дариха на ИС КАМ БЕБЕ!
ПЕТЪР И МАГДАЛЕНА



Младото семейство Магдалена и Пе тър Трендафилови от красивия Ко злодуй дариха 900 лева на ИСКАМ БЕБЕ, събрани на сватбеното им тържество на 21 май т.г. Вместо бу кети, те призоваха гостите си да дарят парите за семейство от Се верозападна България, което се бори за свое дете!
Поклон пред ВАС и приятелите ВИ! Бъдете здрави и благословени, скъпи младоженци! Имаме нужда от човеци като ВАС! Обикаляйте света, радвайте се на живота и нека ВИ спохожда огромно щастие!
54 І БРОЙ 18
НАШИТЕ ДАРИТЕЛИ
И ТАНЯ Още едно младо семейство – Сте фан и Таня Ангелови от Стара Заго ра, отпразнуваха сватбения си ден на 10 септември и дариха за каузата ни 1000 лева! МЕТОДИ И ПЕТЯ Петя и Методи Йорданови сключи ха брак на 20 август в хотел „Парк Бачиново“ в Благоевград. Радостта от споделеното щастие те изрази ха и пред гостите си, като събраха сумата
СТЕФАН
БЕБЕ Ето я нашата прекрасна ИСКАМ БЕ БЕ-ДАЯНА! На 10 септември, малко преди на на върши 2 годинки, малката ни героиня Даяна стана християнче и беше пос ветена в Тайнството на Божия път! Кръщенето се случи в едно свято място за нас от ИСКАМ БЕБЕ – Тро янския манастир! Мама Ивелина и татко Васко от лю бимия ни Троян решиха, вместо цве тя, да помолят гостите на кръще нето, да дарят паричките за каузата на ИСКАМ БЕБЕ. След 4 години борба за бебе, много вяра и подкрепа от приятели, свър зани със семейството на ИСКАМ БЕБЕ, Ивелина стана мама на Дая на! Огромни благодарности към д-р Шефкетова, д-р Райков и д-р Апос толова от Аджибадем Сити Клиник УМБАЛ Токуда. Днес щастливото семейство ни до

каза, че няма граници за благодар ността и че тази благодарност е истинска само тогава, когато се предаде нататък! Ние, от ИСКАМ БЕБЕ, приемаме с бла годарност направеното дарение! И нека се множи Доброто! ОТ
УЧЕНИЦИТЕ С

ЛЮБОВ
Благодарим от сърце на три класа от три училища в Димитровград, които подкрепиха каузата на ИСКАМ БЕБЕ и продължиха инициативата на НЧ „Христо Ботев“, Димитровград.

Бяха събрани следните суми: • 3 „б“ клас от ОУ „Алеко Константи нов“ с класен ръководител г-жа Ма риана Стоянова – 765 лв.
• 7 „а“ клас от ПМГ „Иван Вазов“ с класен ръководител г-н Живко Же лев – 433 лв.
• 5 „б“ клас от ОУ „Пенчо Славейков“ с класен ръководител г-жа Добринка Донева – 200 лв. Бъдете здрави и нека доброто ви се връща!
ЮБИЛЕЕН ФОЛКЛОРЕН

КОНЦЕРТ
5 217 лева бяха събрани от Юбилей ния благотворителен фолклорен концерт на НЧ „Хр. Ботев 1902“ в Ди митровград в подкрепа на каузата на ИСКАМ БЕБЕ. Събитието се проведе в Спортна зала „Младост“. В програ мата се представиха ДТС „Тракия” –малка и голяма група, ТС „Тракия“, ГНХ „Тракия 1“, ГНХ „Тракия 2“, ГНХ „Тракий ски ритми”, Солисти при читалище то, ФГ „Тракийски гласове”.
55 БРОЙ 18 І ОДА ЗА ДОБРОТО ДОБРОТО Е ЗАРАЗНО: 900 ЛЕВА СЪБРА СЕМЕЙСТВО ОТ ТРОЯН В ПОДКРЕ -
ПА НА ИСКАМ
ИНИЦИАТИВА НА KOLIE.BG За периода октомври-декември кли ентите на Kolie.bg, закупили сребър но колие от колекция „България“, ще
подпомогнат лечението на семейства с репродуктивни проблеми. Инициа тивата е по идея на Kolie.bg, които заедно с фондация „Искам бебе“ реализи рат благотворителната кампания „Колекция България – мистични бижута с кауза“ в подкрепа на семействата, които се борят за бебе. Кампанията се осъществява изцяло онлайн – на сайта kolie.bg, като част от всяка продажба на сребърно колие от колекция „България ще бъде дарена на фондацията.


ДАРЕНИЕ ОТ
INFOSOURCE
5 440 лв. е сумата, дарена от InfoSource на фондация „Искам бебе“, с която ще бъде подпомогнато ле чението на семейство, борещо се за бебе. Каузата на фондацията е из брана от служителите на InfoSource като една от няколкото, които да бъдат подкрепени в програмата им за корпоративна социална отговор ност. От компанията уточняват, че през тази година 20% от приходи те на InfoSource ще бъдат дарени на различни социални каузи.
Почти 4 часа продължи грандиозният концерт-спектакъл по случай 50-годиш ния юбилей на Мирела Славова в Злато град! Препълнена зала, изключителни про фесионалисти на сцената, много сълзи от радост, изненади за юбилярката и ис тинска наслада за духа – това беше усе щането на всички присъстващи! Мария Янева и Радина Велчева изказаха ог ромната благодарност от името на ИС КАМ БЕБЕ на семейство Мирела и Недялко Славови за дългогодишната подкрепа на каузата и ентусиазма, с който продължа ват да творят добро в името на това да се раждат повече желани деца в Бълга рия! Семейство Славови е удостоено от УС на фондация „Искам бебе“ с Наградата „Ангел на Благодарността“! Благодарим на участниците в концерта – уникалния „Ансамбъл Родопа“, любима та актриса на всички златоградчани Ири на Маринова, младата певица Симона За горова, талантливата Емилия Валенти и гайдарски състав „Делю Хайдутин“ – та лисманът на Златоград. Дарението от 5610 лева се предоставя на семейство от Златоград, което от дълги години се бори за своя рожба. Искрено вярваме, че заедно ще случим Чу дото на живота.

56 І БРОЙ 18
1226 ЛЕВА СЪБРА БЪЛГАРСКО КРАФТ ОБЩЕСТВО В ПОДКРЕПА НА ИСКАМ БЕБЕ! Координаторът ни за Пловдив Еми Христозова присъства на първата кон ференция на Българско Крафт Общество, организирана от прекрасните мо мичета на снимката. По тяхна инициати ва събитието ще подпомогне каузата на фондация „Искам бебе“. Мили момичета, бла годарим ви за подкре пата, красивите идеи и вдъхновението! 5610 ЛЕВА Е ДАРЕ НИЕТО ОТ БЛАГОТВО РИТЕЛНИЯ КОНЦЕРТ НА МИРЕЛА СЛАВОВА

В статията от предишния брой на учихте, че възпалението е първична та реакция на имунната ни система и целта му е да възвърне или да запа зи динамичното равновесие в тяло то, което поддържа живота. Разбра хте още, че възпалението може да бъде остро – с кратка продължител ност, или хронично – което може да продължи месеци, дори години. Научи хте също, че причинителите на въз паление в тялото могат да са външ ни, като вируси, бактерии, паразити и гъбички, или вътрешни, каквито са автоимунните състояния. И накрая споменахме някои фактори в начина ни на живот, които могат да допри несат за активирането на възпали телния отговор в тялото, като: • храни, които не носят достатъчно хранителни вещества и/или внасят токсини в тялото; • цигари и алкохол; • токсини от козметика и почиства
В тази статия ще научите пове че за ролята на храната във възпа лителния отговор в тялото. Храна та е това, с което тялото ни има пряк контакт през повърхността на лигавиците на храносмилателна та система средно по три пъти на ден и по тази причина е основен фак тор както за предизвикване на въз паление, така и за адекватното спра вяне с него. Освен това градивните блокчета, които ни осигурява избра ната храна, се превръщат в част от структурата на нашите органи, тъ кани, клетки и по този начин храната директно участва във възпалител ния отговор в тялото ни. ЗДРАВЕТО НА ХРАНОСМИЛАТЕЛНАТА НИ СИСТЕМА Нека започнем малко по-отдалеч. Първо ще погледнем здравето на храносмилателната ни система.

58 І БРОЙ 18 ФАКТОРИ ЗА ВЪЗПАЛЕНИЕ И ЕНДОМЕТРИОЗА ВТОРА ЧАСТ: ФАКТОРЪТ ХРАНЕНЕ – КАКВА Е РОЛЯТА НА ХРАНАТА ВЪВ ВЪЗПАЛИТЕЛНИЯ ОТГОВОР И ЗАЩО Е ВАЖНО ЗДРАВЕТО НА ХРАНОСМИЛАТЕЛНАТА НИ СИСТЕМА? Автор: Ваня Стойчева, нутриционист, доброволец към фондация „Ендометриоза и репродуктивно здраве” https://www.endometriosis.bg/ https://vanyastoycheva.com/ ПОРЕДИЦА Продължаваме със статиите, от които ще разберете какво пред ставлява възпалението в тяло то,
какви фактори
от ЕНДОМЕТРИОЗА И РЕПРОДУКТИВНО ЗДРАВЕ
се прово кира и как можем да помогнем на тялото да се справи с него.
щи препарати; • неспособност за управление на стреса; • липса на движение; • влошено качество и недостатъчно количество сън и почивка.
Може би се питате защо? Отгово рът е: защото и най-здравословната
диета може да ви донесе проблеми, ако органите, които преработват храната, постъпваща в тялото, не функционират добре.
Устата Може би много пъти сте чували, че храносмилането ни започва в ус тата. Звучи ли ви странно? Уста та ви е мястото, където с помо щта на слюнката и сдъвкването на храната започва процесът на сми лане на въглехидратите. Когато не дъвчем добре храната, цялата ра бота по смилането на въглехидра тите остава за панкреаса. Вслед ствие на това той се претоварва и след време започва да не върши добре работата си. Това води след себе си допълнителни проблеми, ня кои от които трудно свързваме с проблем в храносмилането си. Таки
ва са например прекомерния растеж на кандида и естрогеновата доми нантност.
Стомахът Друг чест проблем на храносмила телната ни система е прекомер ното или недостатъчно производ ство на солна киселина в стомаха. Това са два противоположни пробле ма, но интересното е, че те често се бъркат. Киселината в стомаха ни е доста тъчно силна, че ако попадне върху емайла на зъбите, лесно би го разяла. Тя е предназначена да разгради про теините в храната ни. Благодаре ние на достатъчното количество солна киселина, неактивният ензим пепсиноген се превръща в активен пепсин. Пепсинът е способен да раз гради протеините от храната ни до градивните им елементи – различни аминокиселини.
Солната киселина Другата съществена роля на солната киселина е да държи стомаха стерилен. Тя е толкова силна, че голяма част от патогените, които навлизат в тялото чрез храната, биват унищожени от нейното действие. Слабото производство на солна киселина в стомаха води до разрастване на патогенни бактерии там и съот ветно до възпаление. Другият проблем, който споменах ме, е свръхпроизводството на сол на киселина. Лигавицата на стома ха ни е покрита със защитен слой,

59 БРОЙ 18 І ФАКТОРИ ЗА ВЪЗПАЛЕНИЕ И ЕНДОМЕТРИОЗА
който го предпазва от разяждащо то действие на собствената му киселина. Ако обаче количеството произведена киселина е твърде го лямо, тя започва да разяжда стена та на стомаха и води до язви и въз паление. При наличие на възпаление в сто маха или съответно при недоста тъчно производство на стомашна киселина, разграждането на проте ините в храната не е пълноценно. Когато недобре смлени протеини попаднат в червата и впослед ствие в кръвта, това предразпо
лага към неадекватна реакция на имунната система и съответно до алергии и автоимунни заболява ния. Доброто количество солна ки селина е от съществено значение и за усвояването на минералите от храната.
Тънките черва Тънките черва са основен храносми лателен орган в тялото ни. Те са мястото, където започва истин ското химическо разграждане на храната. Това се случва с помощта на ензими, произведени от клетки

60 І БРОЙ 18
ЕНДОМЕТРИОЗА И РЕПРОДУКТИВНО ЗДРАВЕ
те на тънките черва и панкреаса, и с помощта на жлъчката, произведе на от черния ни дроб. В тънките черва се случва и абсор бирането на вече смляната храна в кръвта, за да достигне до всич ки клетки в тялото ни. Това ста ва с помощта на специфичната му структура, състояща се от мно жество малки власинки. Те увелича ват многократно повърхността му и носят ензими, които завършват разграждането на протеините и въглехидратите. Един от най-често срещаните про
блеми на храносмилателната ни система е повишената чревна про пускливост. Червата ни, освен мяс то за усвояване на храната, са и основна защитна бариера на тя лото ни. Клетките, които изграж дат стените на тънките ни чер ва, са свързани помежду си с много стегнати връзки. В червата обаче може да възникне възпаление вслед ствие на:
• бактериална, гъбична, вирусна ин фекция или такава, причинена от паразити; • чест прием на антибиотици, про тивозачатъчни, нестероидни про тивовъзпалителни, кортикостеро
иди и др.;
• реакция на добавки в храната като консерванти, оцветители и др.;
• дефицити на хранителни веще ства; • недобро храносмилане (включи телно недобро сдъвкване на хра ната); • постъпване на токсини с храната; • стрес. Когато това се случи, стегнатите връзки между клетките отслабват и през тези места могат да преми нат по-големи несмлени частици храна, различни патогени и токсини. Това предизвиква имунен отговор и допълнително възпаление в тя лото. Активирането на имунната система по този начин често води до отключване на алергии и авто имунни заболявания. При наличие на възпаление на чрев ната лигавица, тялото се опитва да я предпази, като произвежда до
пълнително слуз. След време това започва да пречи на функциите по разграждане и усвояване на храна та. Появяват се различни непоно симости. Неусвоената храна пре минава към дебелото черво и храни патогенните бактерии там. Затва ря се порочен кръг.
Дебелото
черво

Когато несмлени и неусвоени заха ри преминават към дебелото черво, те хранят патогенните организми там, най-вече кандида. Този вид гъ бички отделят вещества, подобни на естрогена, и освобождават вече деактивирания естроген в дебело то черво. Това води до симптоми на естрогенова доминантност в тяло то, като:
• кисти на яйчниците и на гърдите; • ПМС; • емоционални проблеми; • ендометриоза. Кандида отделят и ацеталдехид. Това е вещество, което влияе на функцията на ендокринната и имун ната ни системи и на метаболизма ни. Алкохолът влошава симптоми те, предизвикани от кандида. Това се случва, защото той също се разпада до ацеталдехид. Освен това кандида стимулира отделянето на хистамин и влошава симптомите на алергия и възпаление. Дисбалансът на полезните и болес тотворните бактерии в червата води до възпаление в тялото. До та кова състояние се достига при: • честа употреба на антибиотици и стероидни лекарства;
61 БРОЙ 18 І
ФАКТОРИ ЗА ВЪЗПАЛЕНИЕ И ЕНДОМЕТРИОЗА
• тежка диария;
• гладуване;
• непълноценна храна;
• твърде голямо количество храна;
• твърде много силно преработени, нишестени и силно сладки храни;
• прекомерна употреба на алкохол; • употреба на хлорирана вода.
Прекалено голямото количество болестотворни бактерии водят със себе си разнообразни симптоми, свързани с различни системи в тялото ни. Някои от тях можете да видите в таблицата по-долу:
Система Източници Храносмилателна газове, подуване, болки, синдром на раздразне ните черва
Нервна умора, раздразнителност, чести смени на настроенията, нервност, безпокой ство, депресия, проблеми с паметта и концентрацията, главоболие Кожа обриви, екзема, акне Пикочна повтарящи се инфекции на пикочните пътища Репродуктивна повтарящи се вагинални инфекции Ендокринна хормонален дисбаланс, естрогенова доминантност Опорно-двигателна болка и подуване на ставите
Дебелото черво е и един от основните пътища на детоксикация на тялото. Когато този орган не функционира правилно, т.е. когато има наличие на запек или хронична диария, това: • компрометира изчистването на токсините от тялото; • предразполага към стартиране на гнилостни процеси в организма; • храни патогенните бактерии в дебелото черво; • пречи на полезните да се
Дотук научихте защо е важно здра вето на храносмилателната ни сис тема и до какви странични състоя ния могат да доведат проблемите с нея. Научихте също, че при компр тометирана функция на тази основ на система, в тялото се появяват множество неразположения, които изглеждат напълно несвързани с хра носмилането. В следващата статия ще разгледаме основните типове храни, които често водят до възпа ление в тялото, както и с какви ал тернативи можем да ги заменим, за да подобрим здравето на храносми лателната си система.
62 І БРОЙ 18
•
това се случи, започваме да тичаме от лекар на лекар в търсене на причини за неразположенията си, а забравяме да се погрижим за системата, от която и според древната наука за здравето Аюрведа започват всички бо лести – храносмилателната
ЕНДОМЕТРИОЗА И РЕПРОДУКТИВНО ЗДРАВЕ
задържат там;
стартира болестни процеси в тялото, които причиняват проблеми в най-разнообразни системи от органи. Когато
ни система.
предназначена само за обща осведо меност и информираност. Тя няма за цел да служи като медицински съвет и не замества консултация с квали фицирани здравни специалисти, кои то са запознати с вашите здравни и медицински нужди. Използването и възприемането на предоставена та информация е изцяло на ваш риск и отговорност. Съдържанието на тази статия не трябва да се тълкува като диагноза или предложение за ле куване и не трябва да се ползва като такова. Не поставя диагнози, не на значава, не променя и не прекратява назначено медикаментозно или друг вид лечение, както и не заменя квали фицирана медицинска помощ, не е ал тернатива на медицински преглед и/ или проследяване от лекар.
Източници:
• „Nutritional Pathology“ – Dr. Brenda Lessard-Rhead, BSc, ND
• „Staying Healthy with Nutrition“ –Elson M. Haas, MD, Buck Levin, PhD, RD
• „Allergies Disease in Disguise” –Carolee Bateson-Koch DC ND
• „Eating Alive – Prevention Thru Good Digestion” – Dr. John Matsen N.D.
• „Essentials of Human Anatomy & Physiology“ – Elaine N. Marieb, Suzanne M. Keller
63 БРОЙ 18 І ФАКТОРИ ЗА ВЪЗПАЛЕНИЕ И ЕНДОМЕТРИОЗА Очаквайте В следващия брой: Трета част: Факторът хранене – кои са храните, които предизвикват възпаление в тялото? Клетките на тънкото и дебелото черво се обновяват напълно в рамките на 3 до 7 дни. И това се случва с помощта на градивните елементи, получени чрез храната. Клетките на имунната ни система, които играят основна роля във възпалителния отговор на тялото ни, също се обновяват с помощта на храната, която прие маме. Много от функциите на имунната ни система зависят от на личието на витамини и минерали в тялото, които си набавяме отново основно чрез храната. Има храни, които ни носят ценен градивен материал. Има и таки ва, които крадат хранителни вещества от тялото и предизвикват възпалителен отговор. Научете кои са те в следващата статия от поредицата. Информацията
тази
в
статия е

64 І БРОЙ 18 БРЕМЕННОСТ И АРТ „Всяка жена заслужава най-добрата здравна грижа за своята бременност“ Д-р Васил Даскалов е акушер-гинеколог с 30-годишна професионална практика. Роден е в Смолян през 1964 г., завършил е Медицина в МУ-Пловдив през 1988 г. Практикувал е в Бълга рия и в чужбина, има десетки специализации в областта на репродуктивното здраве, ул тразвукова диагностика, асистирана репродукция и оперативна гинекология. Ръководи собствен Център по репродуктивно здраве в Пловдив. Можете да намерите повече информация на: http://www.invitro-plovdiv.com/.
рабо та на света – да се грижа за майката и нейното неродено бебе, да пома гам на хората да имат деца. За мен няма нищо по-удовлетворяващо в областта на здравеопазването. Вие ставате един от първите свидетели на Чудо то на живота. След толкова години практика, как мислите – кога и как се появява животът? През дългия си професионален път съм водил хиляди раждания и всеки път се вълнувам при появата на нов живот. Чисто медицински погледна то, животът се появява с първата глътка въздух след раждане. Но на практика знаем, че вътреутробно то развитие на бебето е истинско чудо, което започва с оплождането, грандиозните процеси на развитие и органогенеза, с включването на гене тични фактори и епигенетични въз действия, влияние на околната среда и т.н. Иска ми се да мисля, че живо тът възниква с любовта на двама души, но ще оставя на философи те да търсят отговор на този сло жен въпрос. Какво, всъщност, е фе талната

ният обхват е диагнозата, прогно зата, лечението и профилактика та на малформации и заболявания на бебето вътреутробно. Също така извършването на диагностична и лечебна дейност при случаи, сигнали зирани от антенаталния скрининг и акушерски операции. В нея участват различни специалности – акушер ство и гинекология, ембриология, ме дицинска генетика и молекулярна би ология, неонатология и т.н. Лекарят специалист по фетална медицина трябва да има квалификации както по отношение на нормалното раж дане, така и в областите образна диагностика, ехография, в това чис ло двуизмерна, триизмерна и допле рова, оперативно акушерство, ме дицинска генетика и ембриология.
Освен това лекарят трябва да има практически опит и в извършване то на гинекологичните операции (оперативно отстраняване на пато логични материи, възстановяване на
анатомични структури, задържане на бременност, прекъсване на пато логична бременност по медицински показания, както и операции за овла дяване на усложнения на раждане, аборт и АГ операции).
Занятие за цял живот Сами разбирате, че при тези изисквания и сложен обем от теоретични и практически познания и опит, специалист по фе тална медицина не се ста ва лесно и бързо, изисква многогодишен труд в различните направления на специалността. Като до бавим и непрекъснато развиващите се области на науката и технологиите, това си е едно занятие за цял живот.
65 БРОЙ 18 І „ВСЯКА ЖЕНА ЗАСЛУЖАВА НАЙ-ДОБРАТА ЗДРАВНА ГРИЖА ЗА СВОЯТА БРЕМЕННОСТ“ Д-р
хте
на акушер-гине
колог
на
Щастлив
да
на
го
медицина? Това е интердисциплинарна об ласт в медицината, която отразя ва съвременното ниво на познание и технологии. Най-общо казано, ней
Даскалов, защо избра
пътя
-
в необятното поле
медицината?
съм
работя в този дял
медицината, в който има най-мно
радост. Имам най-хубавата
което е малко застъпено в нашето здравеопазване, но е много важно. Какво представлява скринингът в първи тримес тър при бременност след лечение на безплодие? Стандартното прилагане на комби ниран (ултразвуков и биохимичен) скрининг за хромозомни аномалии има някои особености при жени след инфертилитет. При хромозомно нормални бременности, постигнати след асистирана репродукция, някои особености водят до повишаване на процента фалшиво положител ни резултати за риск от тризомия 21 (синдром на Даун), независимо от другите показатели при скрининга. Затова освен стандартните пара метри, трябва да се уточнят след ните допълнителни фактори – дали е прилагана стимулация на овулация та и с какви медикаменти, приложе на ли е методика по инвитро оплож дане, има ли трансфер на размразени ембриони и дали е използвана донор ска яйцеклетка. Внимателно тряб ва да се определи гестационната възраст при бременности, постиг нати чрез инвитро оплождане, тъй като протоколите за стимулация са различни, както и дните за ембрио трансфер, затова вместо дата на последна редовна менструация, се въвежда датата на овариална пунк ция – това респективно е датата на овулация. Скринингът се затруднява и в си туациите на компрометирана мно гоплодна бременност, когато към деня на скрининг съществува и не развиващ се ембрион. В такъв случай се предлага скринингът да се извър

66 І БРОЙ 18
При Вас идват много жени, при които най-после се случва желаното забременяване. А сега накъде? Разкажете ни за най-важните стъпки, които всяка жена трябва да направи след установяването на бременност? Алгоритъмът за проследяване на бременност е относително ясен, като търпи развитие през години те и се адаптира индивидуално към всяка бременна жена. В авторската брошура „Моята бременност“ съм описал какво препоръчвам да пра ви бременната жена – тя е безплат на и може да се изтегли от моя сайт. Нека да отбележа, че грижата за бременността започва преди това с профилактика и превенция – нещо, БРЕМЕННОСТ И АРТ
ши само на базата на ултразвукови маркери. Най- честите проблеми, които наблюдавате при жените в първите 12 сед мици от бременността, когато и страхът е най-голям? Възможни решения? Доскоро битуваше мнението, че в първите няколко седмици медици ната не може да помогне, ако една жена започне да абортира, и лекарят е безсилен свидетел на случващата се трагедия. Това е била и причина та нашите майки и баби да са криели бременността си в първите месе ци, защото голяма част от бремен ностите са приключвали неуспешно. Сега вече знаем, че това не е така, а има заболявания и състояния при майката, които могат да бъдат ус пешно профилактирани преди заче ване, изследвани и лекувани преди и по време на бременността. Познава нето на причините за ранните спон танни аборти и механизмите за по влияване ни позволяват в голям брой ситуации да се намесим успешно и с правилна терапия
следява като рискова. Това означава, че за тази бременност трябва да се положат различни грижи, специфич но свързани с причините за безпло дието. Бременността не слага край на инфертилитета, а поставя нови предизвикателства пред бременна та жена и проследяващия лекар. Тън костите в проследяването на та кава рискова бременност изискват познаване на причините за инферти литет, методите за лечение, специ фиката на отделните асистирани репродуктивни техники, медицин ските особености на бременност, постигната след конкретен вид ле чение, както и психиката на бъдеща та майка и нейния партньор.
Рискови фактори Ще спомена само някои рискови фактори, като например проблеми с пла центацията, пренос на генетични заболявания от единия родител на бебето, многоплодна бременност, известно увеличаване на риска от вродени анома лии, което макар и мал-
е предиз викателство да се проследи. Стан дартните рискове при многоплодна бременност, независимо от начина на забременяване, са добре извест ни. В огромния процент многоплод ните бременности след лечение на инфертилитет са дизиготни. Мо нозиготните бременности в обща та популация са 0.3%. След инвитро оплождане рискът за монозигот на бременност се увеличава на 2%. Възможно е и съчетание от моно- и дизиготни плодове. Всички се радва ме на близнаците, но специалистите и малко треперим и се притеснява ме за добрия изход на такава бре менност. Затова и тяхното просле дяване е

67 БРОЙ 18 І
Различна ли е бременност та след асистирана репродукция и има ли нещо по-особено, което се налага да правят бъдещите майки? Много различна. Това, естестве но, не е мое лично мнение, то е от разено в съвременната медицина и в препоръките бременността след безплодие в анамнезата да се про
да доведем бре менността до успешно раждане.
ко, създава тревожност и изисква допълнителни мерки, както и проблеми с износването и по-висок процент оперативно родоразрешение. Тъжно е, че това не е отразено в наша та здравна доктрина. Често след асистирана репродукция се радваме на бременност с близнаци. Какво е особеното при проследяването й? Многоплодната бременност, неза висимо как е постигната,
на
интервали и по-интензивно, в сравнение с едно плодните. За навиците и ежедневие то на бременната – да пие ли кафе, колко са вредни цигарите, чаша вино позволена ли е, да взима ли витамини? Обичайно казваме, че бременната „ВСЯКА ЖЕНА ЗАСЛУЖАВА НАЙ-ДОБРАТА ЗДРАВНА ГРИЖА ЗА СВОЯТА БРЕМЕННОСТ“
по-кратки
жена не е болна и не бива да променя драматично навиците си. Изключе ние правят тези неща от ежедневи ето, които биха могли да навредят на бебето – например тютюнопу шене, прием на алкохол или недои мъчно хранене. Опитвам се да убеж давам моите бременни да живеят максимално здравословно, да се дви жат и да приемат необходимите им витамини и минерали, да избягват някои вредни и потенциално опас ни храни, да внимават с килограми те, да следят кръвното си редов но и т.н. С каква апаратура работите във Вашия център? Мислите ли, че добрият лекар не е толкова зави сим от апарата, а по-скоро от умението, знанието и практиката да „вижда“ и „предсказва“ какво и как се случва в утробата? Добрата ултразвукова апаратура с нейната висока разделителна спо собност е задължително условие да се постави навременна и прециз на диагностика. От това зависи как ви мерки ще предприемем за успешна бременност. Разбира се, никой апа рат не работи сам и лекарят е този, който поставя диагнозата на ба зата на своите умения, квалифика ция и опит. Всеки вижда това, кое то знае. Следва трудният въпрос с „предсказването“ – всъщност

68 І БРОЙ 18
е
за развитието на даде но
или усложнения на бре менността,
също до
степен зависи от способностите на лекаря, от неговите широки позна ния и от доброто му сътрудничест во с други специалисти. Квалификация Заради важността на апа ратурата съм инвестирал в един от най-добрите съвременни ултразвукови апарати, както и в друга техника, но също така и в своята непрекъсната квалификация. В тази връзка разбрахме, че Ваша снимка е била избрана за юбилейното списание на професионалната организация ISUOG (Международна организация по ултразвук в акушерството и гинекологията). Разкажете ни повече. Аз съм член на ISUOG от много го дини, защото смятам, че трябва да се равняваме на най-добрите. Орга низацията обяви конкурс по случай своята 30-годишнина и всеки лекар по света имаше право да участва с 3 снимки, които са вдъхновяващи БРЕМЕННОСТ И АРТ
това
прогнозата
заболяване
което
голяма
демонстрират нивото на съвре менната апаратура. Изпратих като на шега снимки от своята ежеднев на практика, без да ги обработвам и да се старая да получи образи като за списание, и забравих за конкурса. Беше вълнуващо да получа писмо, че една от моите снимки е избрана да участва в този юбилеен брой. Най-добрата здравна грижа Приемам това като знак, че в България специалистите можем да пред ложим здравна помощ на ниво, съизмеримо с това на най-добрите здравни системи. Всяка жена заслужава най-добрата здрав на

начин? Ембрионалното развитие на бебето, формирането на неговите органи и системи залага основата на здравето му след раждането. Известни са мно жество фактори, които могат да по влияят позитивно върху развитието на бебето, или обратно – да навре дят (ако например жената е изложе на на токсини, инфекции или силен стрес). Медицината напредва с едри крачки в тази насока, като се опит ва да предвиди дори предразположе ния към някои заболявания, или обра тно, доколко ще е умно и талантливо едно дете. Ще ви дам само няколко примера, кои то ме вдъхновяват силно. Няколко екипа от учени работят по вътре утробната хирургия на плода, за да могат да намерят най-подходящо то време, начини и методи за опера ция на лицеви дефекти, за да няма бе лег от тази намеса, за корекция на незатворен гръбначен стълб и дру ги малформации. Също така дълги го дини се правят опити да се откри ят гените, които се експресират при някои заболявания, например тризо мия 21 (синдром на Даун), както и да се разбере въздействието на кои лекар ства вътреутробно може да помог не на развитието
случаи с: „Успешна бре менност!“. Това е най-доброто поже лание от страна на лекаря и аз с удо волствие го казвам. Но понякога съм длъжен да съобщя недобри новини на моите пациенти, това е част от мо ята работа. Тогава им пожелавам да намерят най-правилното решение за тяхната ситуация.
Как отговаряте на честите въпроси от бременната: „Какво означа ва, когато бебето си смуче пръстчето в корема?“, „Усмихва ли се бебето ми?“? Пред нас се открива цяла една нова, неразгадана Вселена – вътреутроб ното поведение на бебето. И да, то се усмихва, смуче си пръстчето, хъл ца, играе си с пъпната връв, облизва се и се прозява, гълта, пишка, мръщи се... Тези неволеви прояви на физиче ска активност и емоции са прият ни за гледане и създават връзка меж ду родителите и тяхното неродено още бебе.
69 БРОЙ 18 І
и
грижа за своята бремен ност. Убеден ли сте, като лекар, че още в корема на мама, бебето може да формира черти от характера си в бъдещето? Например – четенето на книжки или слушането на определена му зика влияе ли на бебето по някакъв
на невроните, за да е по-лесно на тези деца след раждане. Вътреутробното лечение със ство лови клетки също е на дневен ред, така че тепърва ще откриваме колко е значим този период от развитието на детето. С какви думи изпращате от кабинета си бременната жена, която само пре ди 30 минути е влязла при Вас със своите страхове и сълзи? В повечето
Как може да се опише
Ваша среща с детето,
то живот сте
ли от точицата до първия плач? Какво Ви носи тази емоция? Няма подходящи думи, с които да оп иша тази емоция. Благодарен съм на всеки родител, който ми изпраща снимки, или ми позволява да се снимам с детето му, защото това ме зареж да с нови сили да продължа да се раз вивам в своята професионална об ласт. „ВСЯКА ЖЕНА ЗАСЛУЖАВА НАЙ-ДОБРАТА ЗДРАВНА ГРИЖА ЗА СВОЯТА БРЕМЕННОСТ“
една
чий
проследи

70 І БРОЙ 18

71 БРОЙ 18 І







72 І БРОЙ 18
Трикове за дома и храната
Сготвени-приготвени
73 БРОЙ 18 І



74 І БРОЙ 18

75 БРОЙ 18 І

76 І БРОЙ 18

77 БРОЙ 18 І

78 І БРОЙ 18
79 БРОЙ 18 І
БОРБА ЗА
ЖИВОТ
Д-р Маргарита Таушанова е онколог в клиниката по Медицинска онкология на МБАЛ „Надежда“. Завършила е медицина в Медицинска академия – София. Придо бити специалности: Вътрешни болести и Онкология. Защитена дисертация на тема „Диагностика и лечение на тройно негативен карцином на гьрдата“. Член на ESMO, ASCO, БАМО, Бьлгарска асоциация по медицинска онкология. Има над 50 публикации в български и чужди издания. Любимото й хоби са пътешествията до нови и екзотични дестинации.

Д-р Таушанова, защо избрахте лекарската професия за своя съдба и какво Ви мотивира да продължавате всеки ден да помагате на пациентите с рак? Моят избор на професия може би не е случаен. Майка ми е медицинска се стра и като дете често посещавах болницата, където работеше. Дори и сега, когато имам достатъчно дъ лъг трудов стаж, отново ако тряб ва да избирам професия, това би
било лекарската. Разбира се, не съм била наясно с големите изисквания на тази благородна, но и много отго ворна и рискова работа. Да лекуваш болни с онкологични заболявания е още по- голямо предизвикателство. Успехите в лечението през послед ните години в онкологията ми дават надежда, че тези заболявания не са присъда. Те се превъщат в хронични болести, които трябва да се леку вани и контролирани. Вярата в нау ката, нейните постижения са в ос новата на новаторството както в
диагностиката, така и в лечението. Какъв път трябва да измине една млада жена до 35 години, ако току-що е диагностицирана с рак на гърдата? Ракът на гърдата е едно от най-чес тите злокачествени заболявания. През последните години все по-мла ди жени се диагностицират с него. При установяване на карцином на гърдата е необходимо жената да се консултира с екипа от специалисти,
ИМА НАДЕЖДА
80 І БРОЙ 18
които ще провеждат последващо то лечение. След като се уточни стадият на карцинома, се решават видът и последователността на предстоящите терапии – хирургич но лечение, химиотерапия, таргетна терапия, ако е необходима, лъчете рапия, ендокринна терапия. На паци ентката трябва мното подробно да се изяснят стъпките на тяхно то провеждане, последователност, продължителност и вероятни въз можни усложнения, които биха могли да настъпят. При тези млади жени е необходима и консултация за тех ния онкофертилитет, която е ин дивидуална, съобразена с възрастта на пациентката, нейното предсто ящо лечение, желанието за бъдещо поколение.
Медицината вече напредна изключително много. Какви са възможностите на жените в напреднал/ метастазирал рак на гърдата? Какви са Вашите съвети за начина на живот на тези пациентки? Метастатичният карцином на млечната железа е предизвикател ство за лечение на медицинския онколог. Ако преди години един ственият начин е била химиотера пиятата, сега нейното приложение отстъпва място на нови терапии: таргетни агенти, имунотерапия и др. Те не само са с голяма ефектив ност, но и страничните ефекти от тях са много по-леки от цитос татичните агенти. Прилагат се в различни комбинации и терапев тични последователности. В онко логията ставаме свидетели на ре

зултати от лечение, които преди години не бихме и могли да си пред савим. Целите на новите терапии е не само постигане на по-дълъг, сво боден от болест период, по-дъл га обща преживяемост, но и по-до бро качество на живот. И това се постига с висока ефективност. На чинът на живот на пациентките с метастазирало заболяване тряб ва в голяма степен да се доближа ва до нормалния. Запазвайки ритъма си на живот, болните преодоляват и много по-лесно преживения стрес от поставената диагноза.
Разкажете за Ваш случай от практиката, който дава надежда на жените с откологично заболяване?
които показват такава борбеност и желание за живот, каквито здрави жени не притежават. При мен дойде младо момиче на 32 го дини, което беше диагностицира но с карцином на гърдата и метас тази по костите. Влезе в кабинета със своята сестра, помагайки си с бастун, поради болков синдром в кръста. След разговор с нея разбрах, че тя страда от дете и от друго ревматологично заболяване. Започ нах терапия, не знаейки в какъв про цент ще мога да подобря качество то на живот, кога и дали ще успея да стопирам развитието на заболява нето. След около 6 месеца болките по костите постепенно отзвучаха, бастунчето не се ползваше, а усмив ката на моята пациентка не слиза ше от лицето й. Естествено, аз се чувствам щастлива за успеха, който постигнах. Показа ми стимки на мал ката си дъщеричка, която е гимнас тичка и отлична ученичка.
БОРБА ЗА ЖИВОТ
Случаите, които могат да се спо делят, са изключително много, но действително има такива, които не бих могла да забравя. Най-много се възхищавам на млади пациентки, 81 БРОЙ 18 І

усещане – как да се лекува пациентът по най-прецизния и подходящ начин, на което разчитам само на професионализъм. Може ли да се постави
Ситуацията
мно то ранната диагноситка, лечение то, проследяването на онкологично болните. Целият медицински персо нал беше поставен в неясна, непо зната до този момент ситуация, съ ществуваха много неясноти, а може би и ще има и още по отношение на тази пандемия. Но независимо от това е вярна насоката в поведение то. Ваксините са важно и необходи мо условие за по-лекото протича не на заболяването. Те не само не са противопоказани, а са и необходи ИМА НАДЕЖДА 82 І БРОЙ 18
ОБЩА КАУЗА В подобни ситуации борбата за живот при тези пациенти се превръща в обща кауза. Естествено, същест вува и потиснатото у мен чувство, че на този етап от лечението съм щастлива, безкрайно удоволет ворена, но заболяването може в даден момент да се активира отново. Тогава идва другото
ваксина против COVID-19 при жени, диагностицирани с рак на гърдата?
с COVID-19 усложни
ми да се поставят при онкологично болните. Тава са и основните пре поръки на световните и европейски асоциации по онкология за нашите болни. Основен въпрос е и собстве ното убеждение от приложението им, както и вярата в науката. Какво казвате на пациен тите си, за да ги окуражите да продължат битката
или дни. Из лизайки от болничното заведение, живътът им трябва да поеме нор малните си рамки. Моята цел е да дам надежда на болните, да им се внуши, че лечението е един етап от техния живот, който трябва да премине. Естествено, необходими са усилия, но не и отчаяние, самосъжа ление. Подкрепата на лекаря е важна, но е необходима и такава от семей ството, близки

за живот? Разговорите с моите пациенти са
и изключително
търсят съвети както за заболяването, лечението, така и за начина си на живот. При нас те пре карват
и приятели. Искам да убедя моите болни, че се лекуват от едно нелеко заболяване, но не тако ва, което е присъда. Вярата, надеж дата, жаждата за живот са в осно вата на успеха и добрите резултати от провежданата терапия. БОРБА ЗА ЖИВОТ 83 БРОЙ 18 І
ежедневни
необхо дими за тях. Когато идват в Клини ката, те
по няколко часа
д-р малинов, каква е вашата визия за доБрото реПродуктивно здраве – откъде да тръгнат младите хора, ако решат, че искат да имат БеБе? Съвременният човек отдава все по вече значение на личното си вре ме, работа и професионален прос перитет. Родителството е една от най-променящите в живота ни стъпки и за двата пола. Ако това не се случи веднага, стресът от неиз пълнението му е свързан с емоцио нални преживявания, гняв, депресия, брачни проблеми. Една от класиче ските определения за безплодие е не настъпване на бременност в про дължение на една година при двойки в детеродна възраст и шест месеца при жени над 35 години, при регуляр ни полови контакти

важна работата на много
екип, състоящ се от акушер-гинеколог, андролог, ембриолог, имунолог, ендокринолог и психолог. Инвитро процедури те в България са финансово попоносими, отколкото в други ев ропейски държави. Вече повече от 20 години се прилагат различ ни подходи и все по-иновативни техники, които правят лечение то на безплодието още по-ефективно както при жените, така и при мъжете. Пациентките асо циират цялостното преживява не като стресиращо, затова от изключителна важност е емоционалната подкрепа, която получават от страна на медицин ския персонал на клиниката.
в овулационния период. При проблемно забременява не консултацията със специалист е задължителна и голямо значение за успеха има поставянето на точната диагноза за причините за ненастъп ване на бременност, доверието на двойката в лекаря, извършващ пре гледите, консултациите и необходи мите процедури. ВАЖНО Е ДА ЗНАЕТЕ, ЧЕ... ценният Прогестерон Многопрофилен екип В специализираните клиники
все По-често Пациентите говорят за т.нар. Прогестеронов дефицит. какво Представлява това състояние и как се регулира? какви са симПтомите? Редица фактори могат да причи Разговор с д-р Явор Малинов, началник асистирана репродукция и миниинвазивна хирургия в СБАХЛ „Д-р Малинов“. 84 І БРОЙ 18
по репродуктивна медицина е клю чово
профилен
нят дефицит на прогестерон. Сред тях са: преумора, стрес, некачест вена диета, бедна на витамини и ми кроелементи, пушене, употреба на алкохол, прием на антибиотици и контрацептиви, инфекции в гени талната област, нарушена функция на щитовидната жлеза. Профилак тиката на прогестероновия дефи цит е неспецифична. Общият кръвен тест и общото изследване на урина та са задължителни, тъй като поз воляват диференциална диагности ка на определени симптоми. Трябва да има комплексен подход върху ен дометриума, яйчниците, тръбите и имунната система на жената. Така вероятността за по-бързо възста новяване и бременност се увеличава. какво значи „хронично нисък Прогестерон“? как се регулира? Прогестеронът се синтезира в над бъбречните жлези, половите жлези (особено след овулация в жълтото тяло), мозъка и по време на бремен ност в плацентата. Хормонът под готвя лигавицата на матката за приемане на зародиша и контроли ра нормалното протичане на бре менността. Ниските нива могат да се дължат на възпалителни заболя вания на яйчниците, поликистозни яйчници, киста на яйчника, травма или постоперативна яйчникова не достатъчност. Всяка от тези па тологии води до нарушена функ ция на яйчниците и синтеза на малко прогестерон или въобще да не се синтезира. Структурата му е та кава, че той действа на рецептори те, които са предназначени за дру ги хормони (например кортизолови).
Влияе върху цялата ендокринна сис тема, наднорменото тегло и само чувствието. За да се поддържат ре ферентните стойности, трябват почивка, сън и здравословно хране не. Кафето и сладкишите намаляват синтеза на прогестерон. От билки те отрицателно влияние оказват ментата и карамфилът. Поддържате ли твърдението, че стресът е основният враг на Прогестерона? защо е така? Стресът е естествен отговор на тялото към определени ситуации и агресори. Източниците на стрес са много и различни. Обикновено те са свързани с личния живот, взаимоот ношенията, работата или шума и суматохата на ежедневието. Той е изключително отрицателен

При жени ежедневното излагане на висо ки нива на стрес предизвиква пери оди на олигоменорея, т.е. редки или оскъдни менструални цикли.
Кортизол и прогестерон Стресовият хормон – кортизол, се отделя в тялото като отго вор на ситуация, свързана със силен стрес. Това може да бъде травма, хранителна непоносимост, високи нива на естроген, недоспиване, преумора и други. Прогестеронът се свързва с кор тикостероид-свързващ гло булин, който транспортира и кортизола в кръвта. Затова, ко -
85 БРОЙ 18 І ЦЕННИЯТ ПРОГЕСТЕРОН
за
здраве.
пола
яват
на
и системи. Не е въз можно да се предпазим напълно от него, затова по-важно е да се научим да го управляваме ефективно.
фактор
човешкото
И при двата
високите нива на стрес повли
негативно функционалността
много органи
има синергична връзка и това обяснява как силният стрес води до прогестеронов дефи цит. има ли естествен начини да Повишим Прогестерона – начин
гато нивата на кортизол са ви соки, тези на прогестерона на маляват. Между двата хормона
на живот, хранене, среда? Лечението на дефицит на проге стерон може да бъде подкрепено с физически упражнения, здравослов на диета, хомеопатия, акупресура, вода, светлинна терапия. Препоръчително е увеличаване на приема на витамини B и C, които са необходими за поддържане на нивата на прогестерон. Приемане на пове че храни, богати на цинк, като бобо ви растения, кисело мляко, телешко месо. Важно е, разбира се, контро лирането на нивата на стрес, тъй като при стрес тялото освобожда ва кортизол вместо прогестерон. какви видове Прогестерон има и кой се Приема най-Бързо и лесно от организма?
При установен дефицит на проге стерон, когато е необходимо, се при емат лекарства. Прогестероновите бустери трябва да бъдат избрани и предписани от лекар – гинеколог, ен докринолог, репродуктивен специа лист. Могат да бъдат във формата на таблетки, гелове, ампули, супози тории. Не всички прогестеронови препарати
действат еднакво. Тяхната ефектив ност и странични ефекти зависят от вида и начина им на приложение. Пероралният прием на високи дози не се препоръчва, поради своите стра нични ефекти, каквито са гаденето и сънливостта. Същевременно в мал ки дози неговата ефективност при пациенти, провеждащи процедури по асистирана репродукция, може да е недостатъчна. Поставянето на ваги нални гелове и таблетки с прогесте рон не гарантира пълното резорбира не, като в същото време се нарушава балансът на вагиналната флора, как то и комфортът на жените в еже дневните дейности. Иновация В миналото се използваха мастноразтворими прогестеронови инжекции, които бяха болезнени и образуваха стерилни абцеси. У нас вече има и може да се прилага иновативен инжекционен воден разтвор на прогестерон, който може да се инжектира подкожно, безболезнено, от самите пациенти, и осигурява висока бионаличност в организма. Проведено е проучване за предпочитанията на пациентките, оценено с въ просник относно комфорта, лекотата на употреба, удобството, цялостна удовлетвореност, ниво на безпокойство и болка, свързани с вагинално приложен или инжекционен воден разтвор на прогестерон. След завършва не на лечението е установено предпочитание към инжекцион ния воден разтвор на прогестерон.

86 І БРОЙ 18
ВАЖНО Е ДА ЗНАЕТЕ, ЧЕ...



Донорството на яйцеклетки или как майки помагат на бъдещи майки „Станах майка благодарение на дарена яйцеклетка. В тази яйцеклетка е имало толкова много любов, че днес аз съм готова да раздавам щастие...”



88 І БРОЙ 18 Защото ти си ЖИВОТЪТ! 0700 700 17 Национална телефонна линия 0892 475 790 Валентина Иванова donorstvoto@gmail.com info@iskambebe.bg „Аз станах донор. И после още много майки в цяла България чуха и... направиха същата крачка.“ Милена Златкова радиоводещ Радио „Витоша“
Ако имате въпроси или искате да помогнете с информация на близките си, може да се свържете с нас: Главен координатор на донорската програма и координатор за Североизточна България Валентина иванова, тел. 0892 475 790 Координатор за Северозападна България Здравка Гергова, 0898 866 874. Координатор за Южна и Централна България ема Христозова, 0882 430 788. Отговорници за Централна и Северна България Вероника Михайлова, 0886 801 309 Венислава Гарсия, 0897 098898, 0893 008898 Всички ние от фондация „Искам бебе“ вярваме, че точно ТИ СИ ЖИВОТЪТ! Донорството с